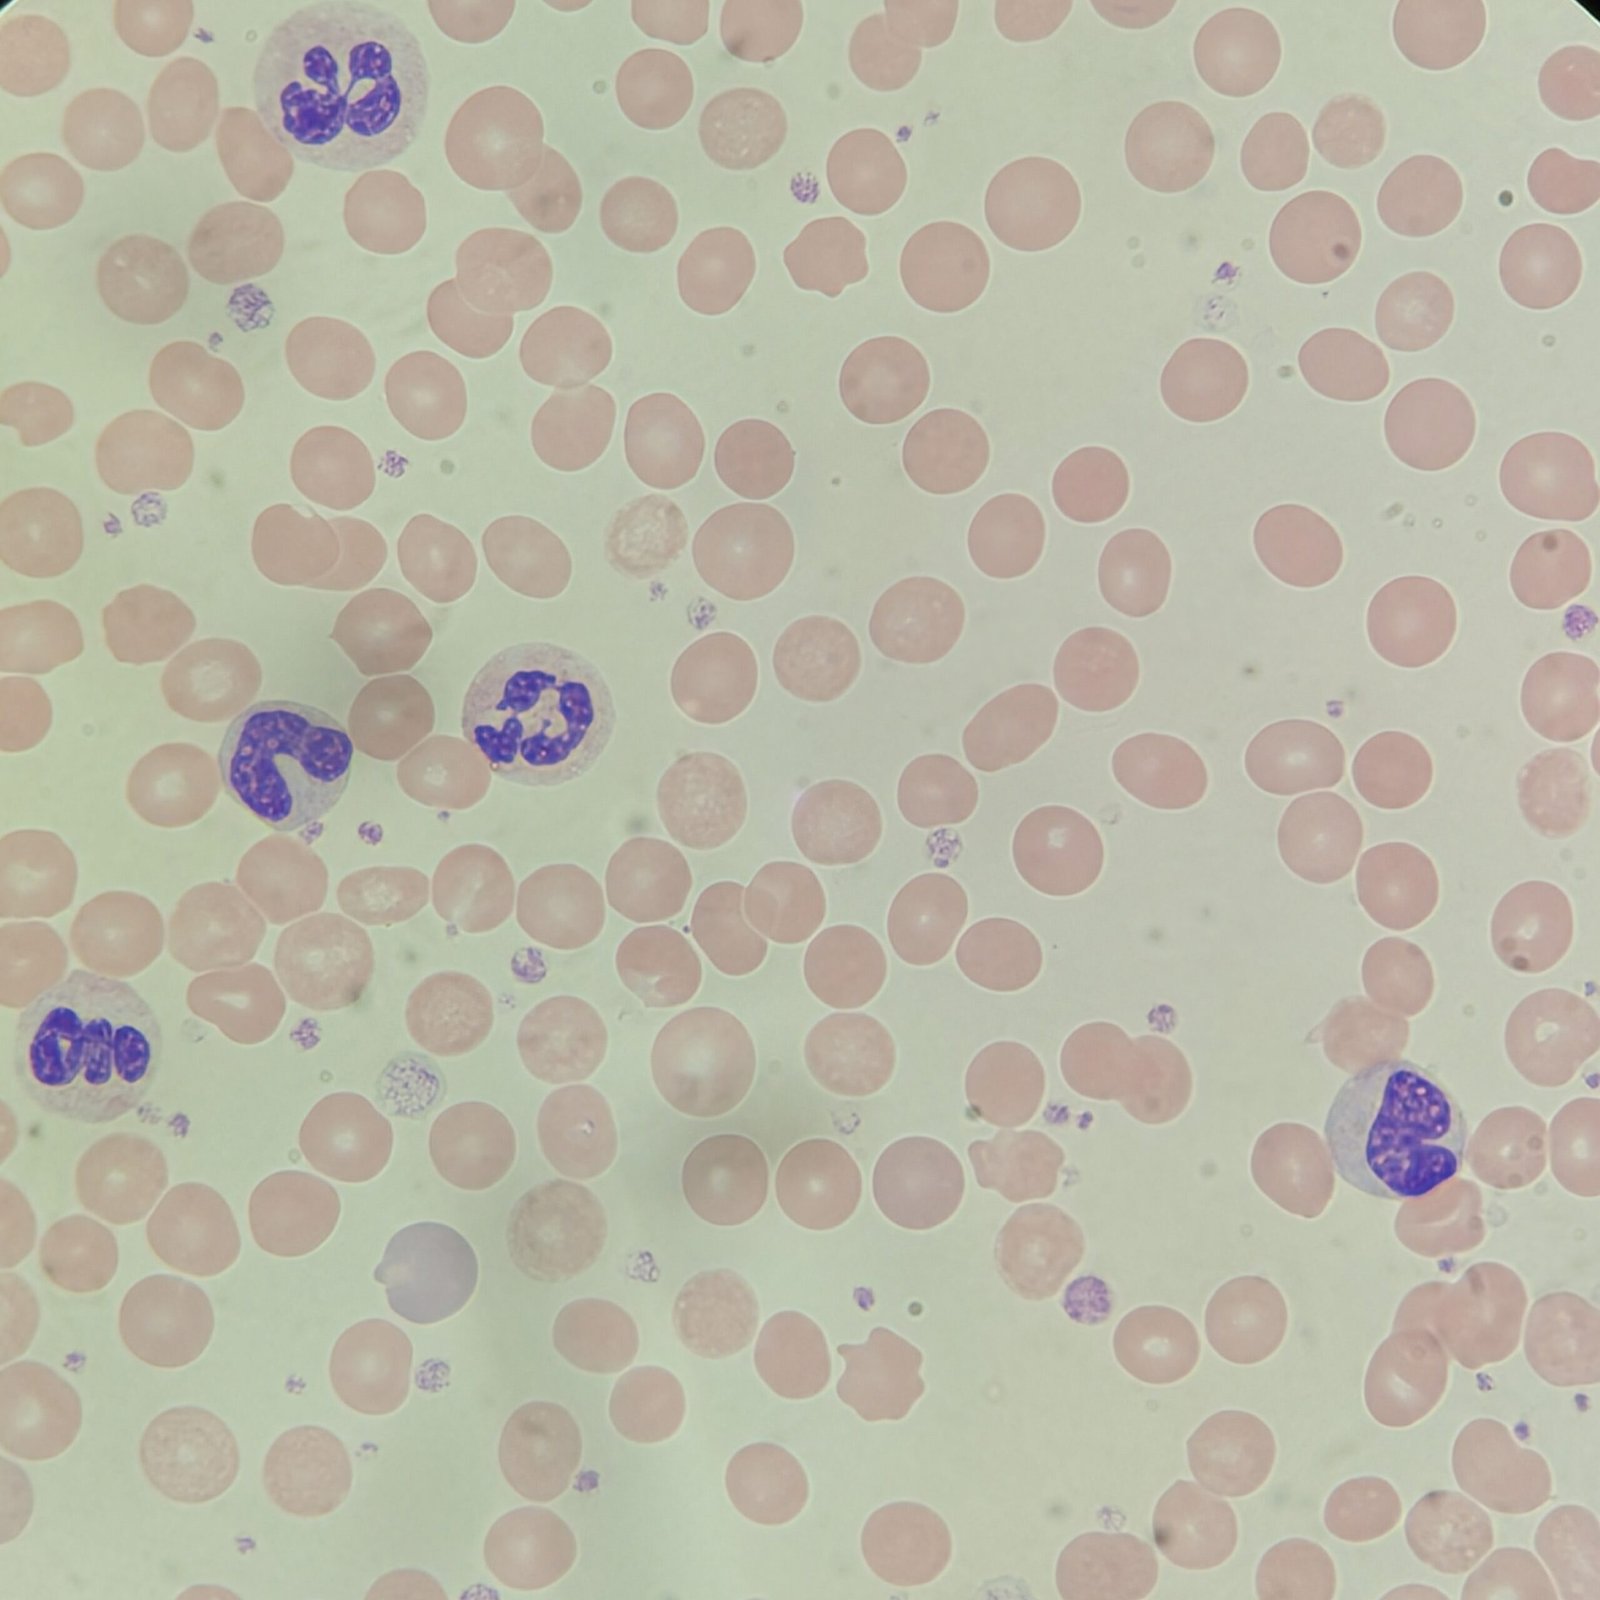
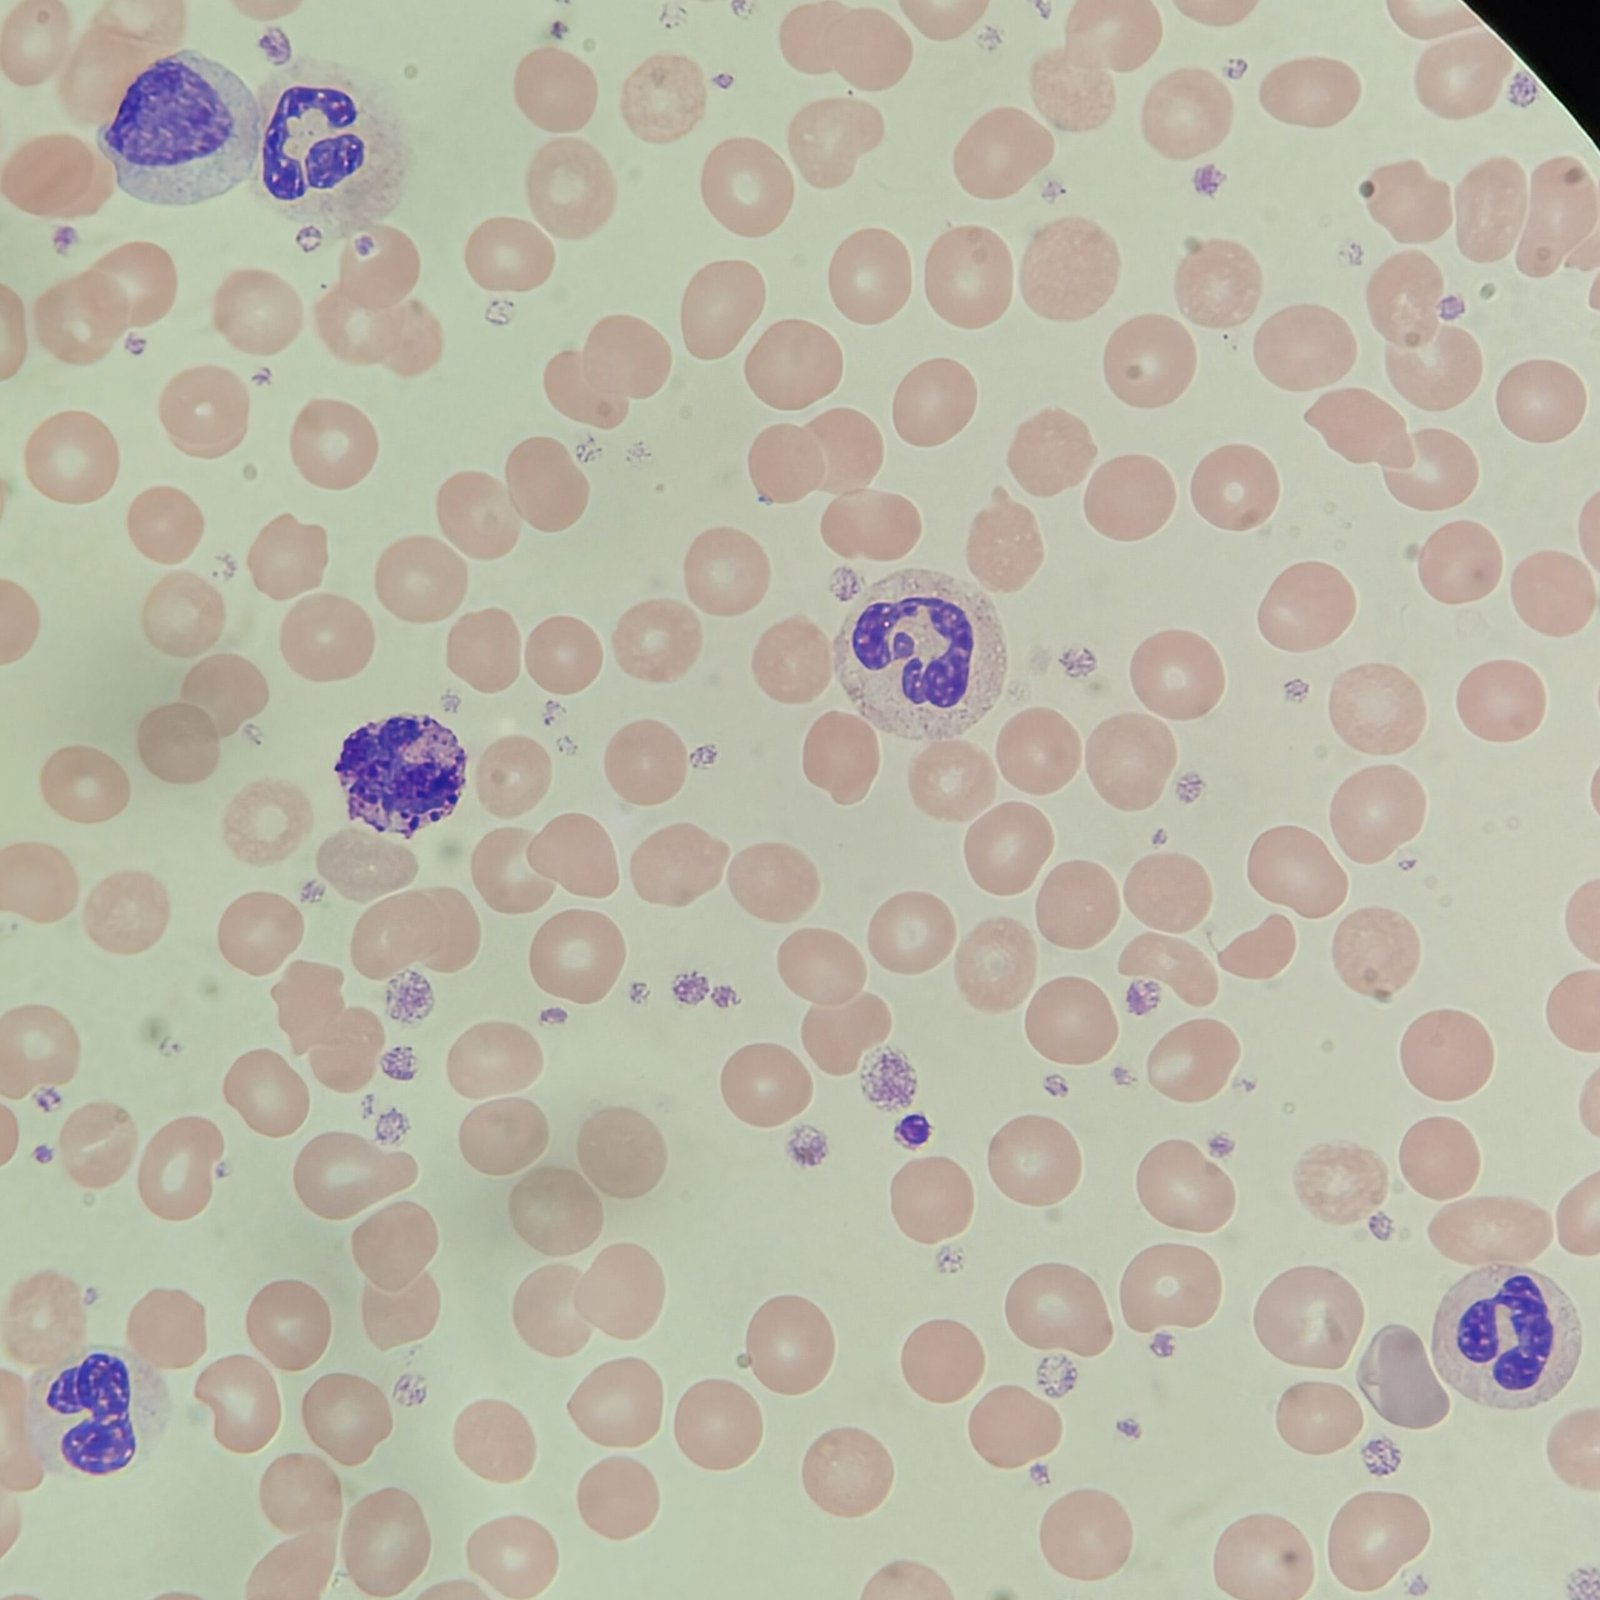
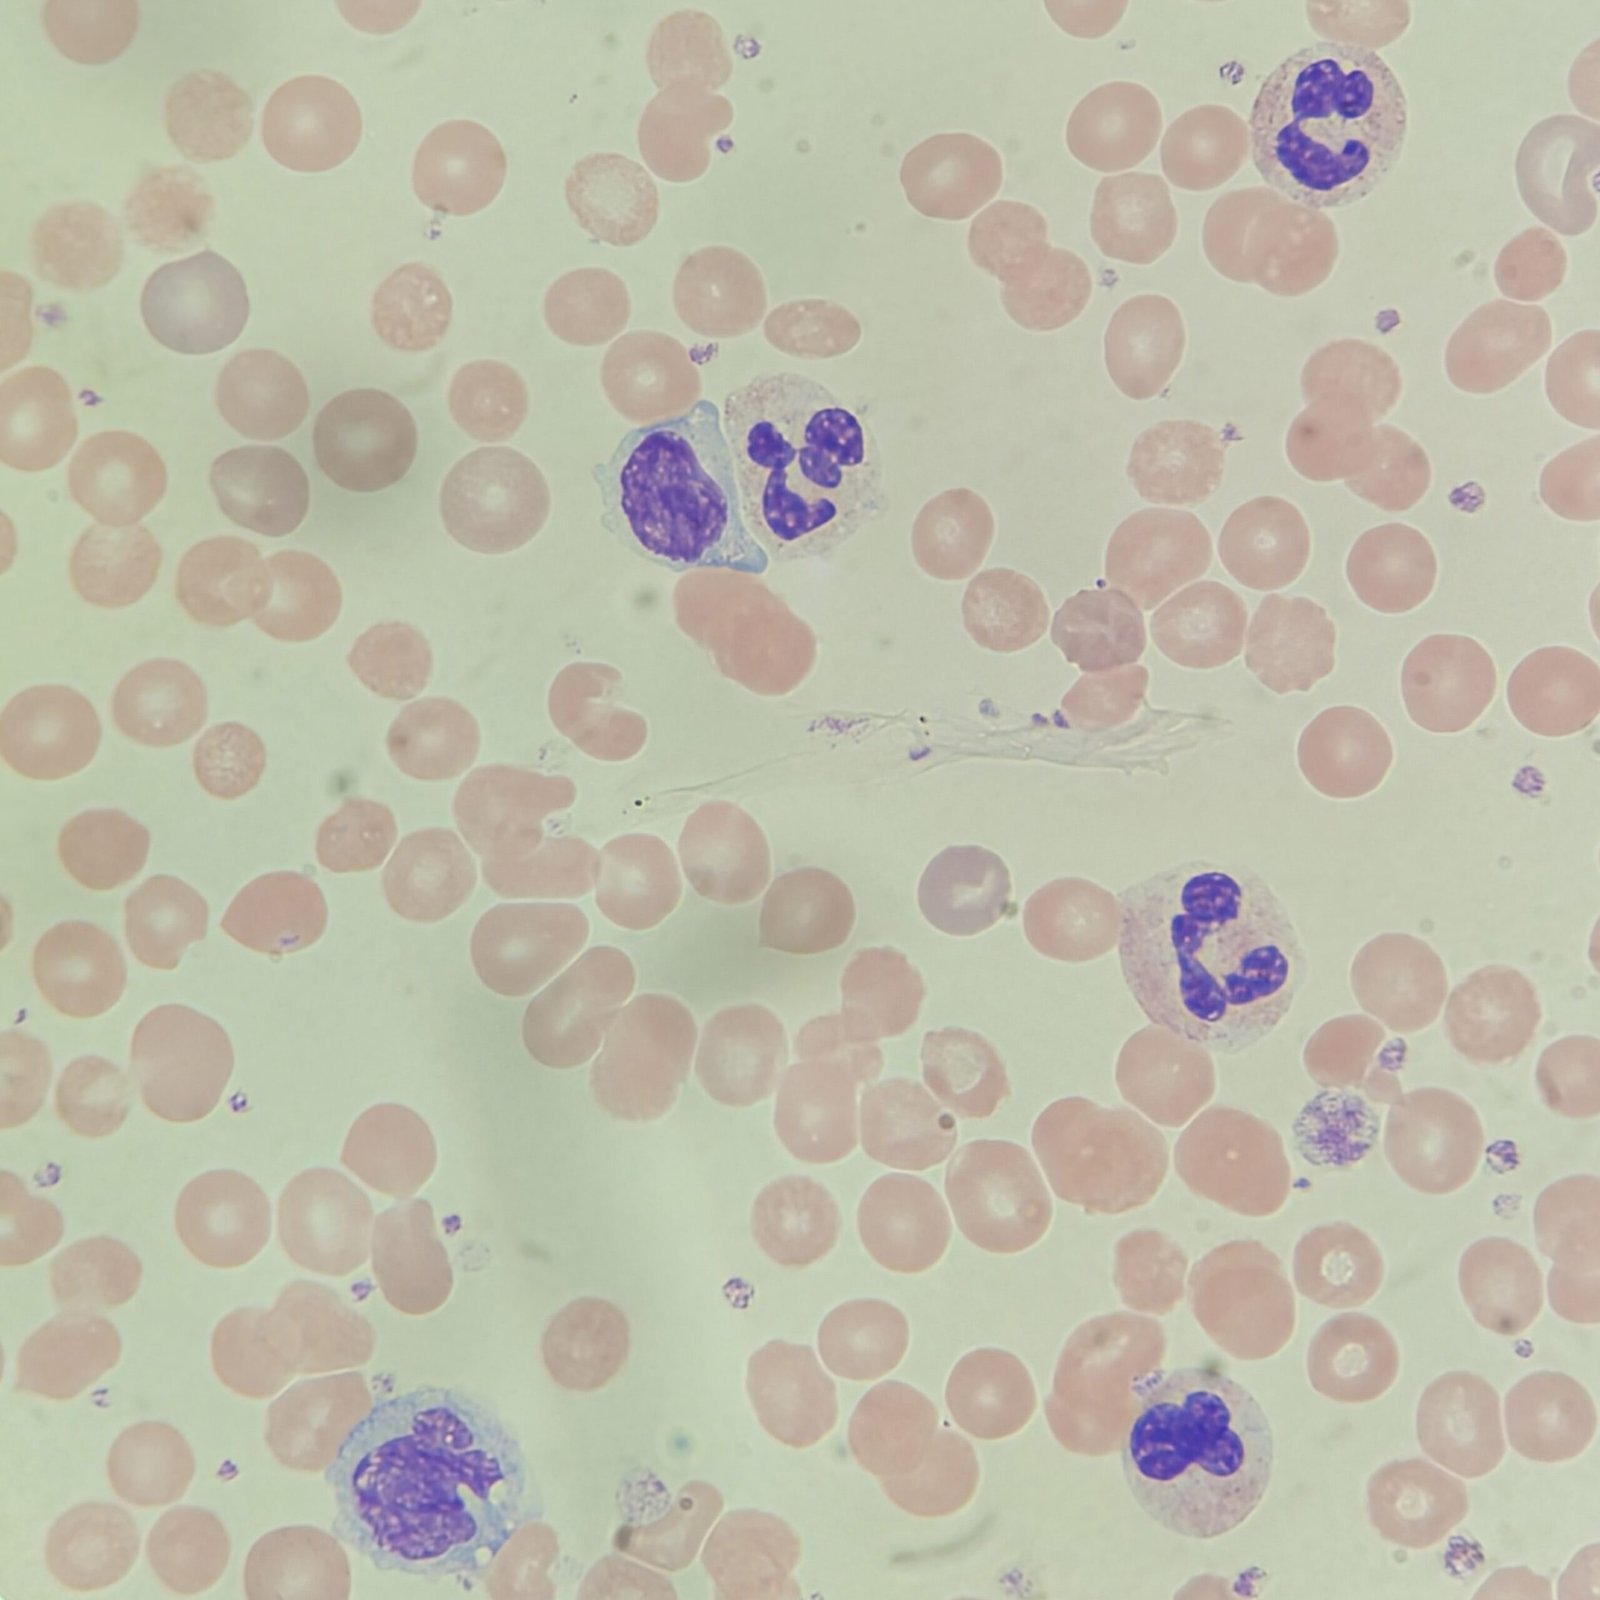
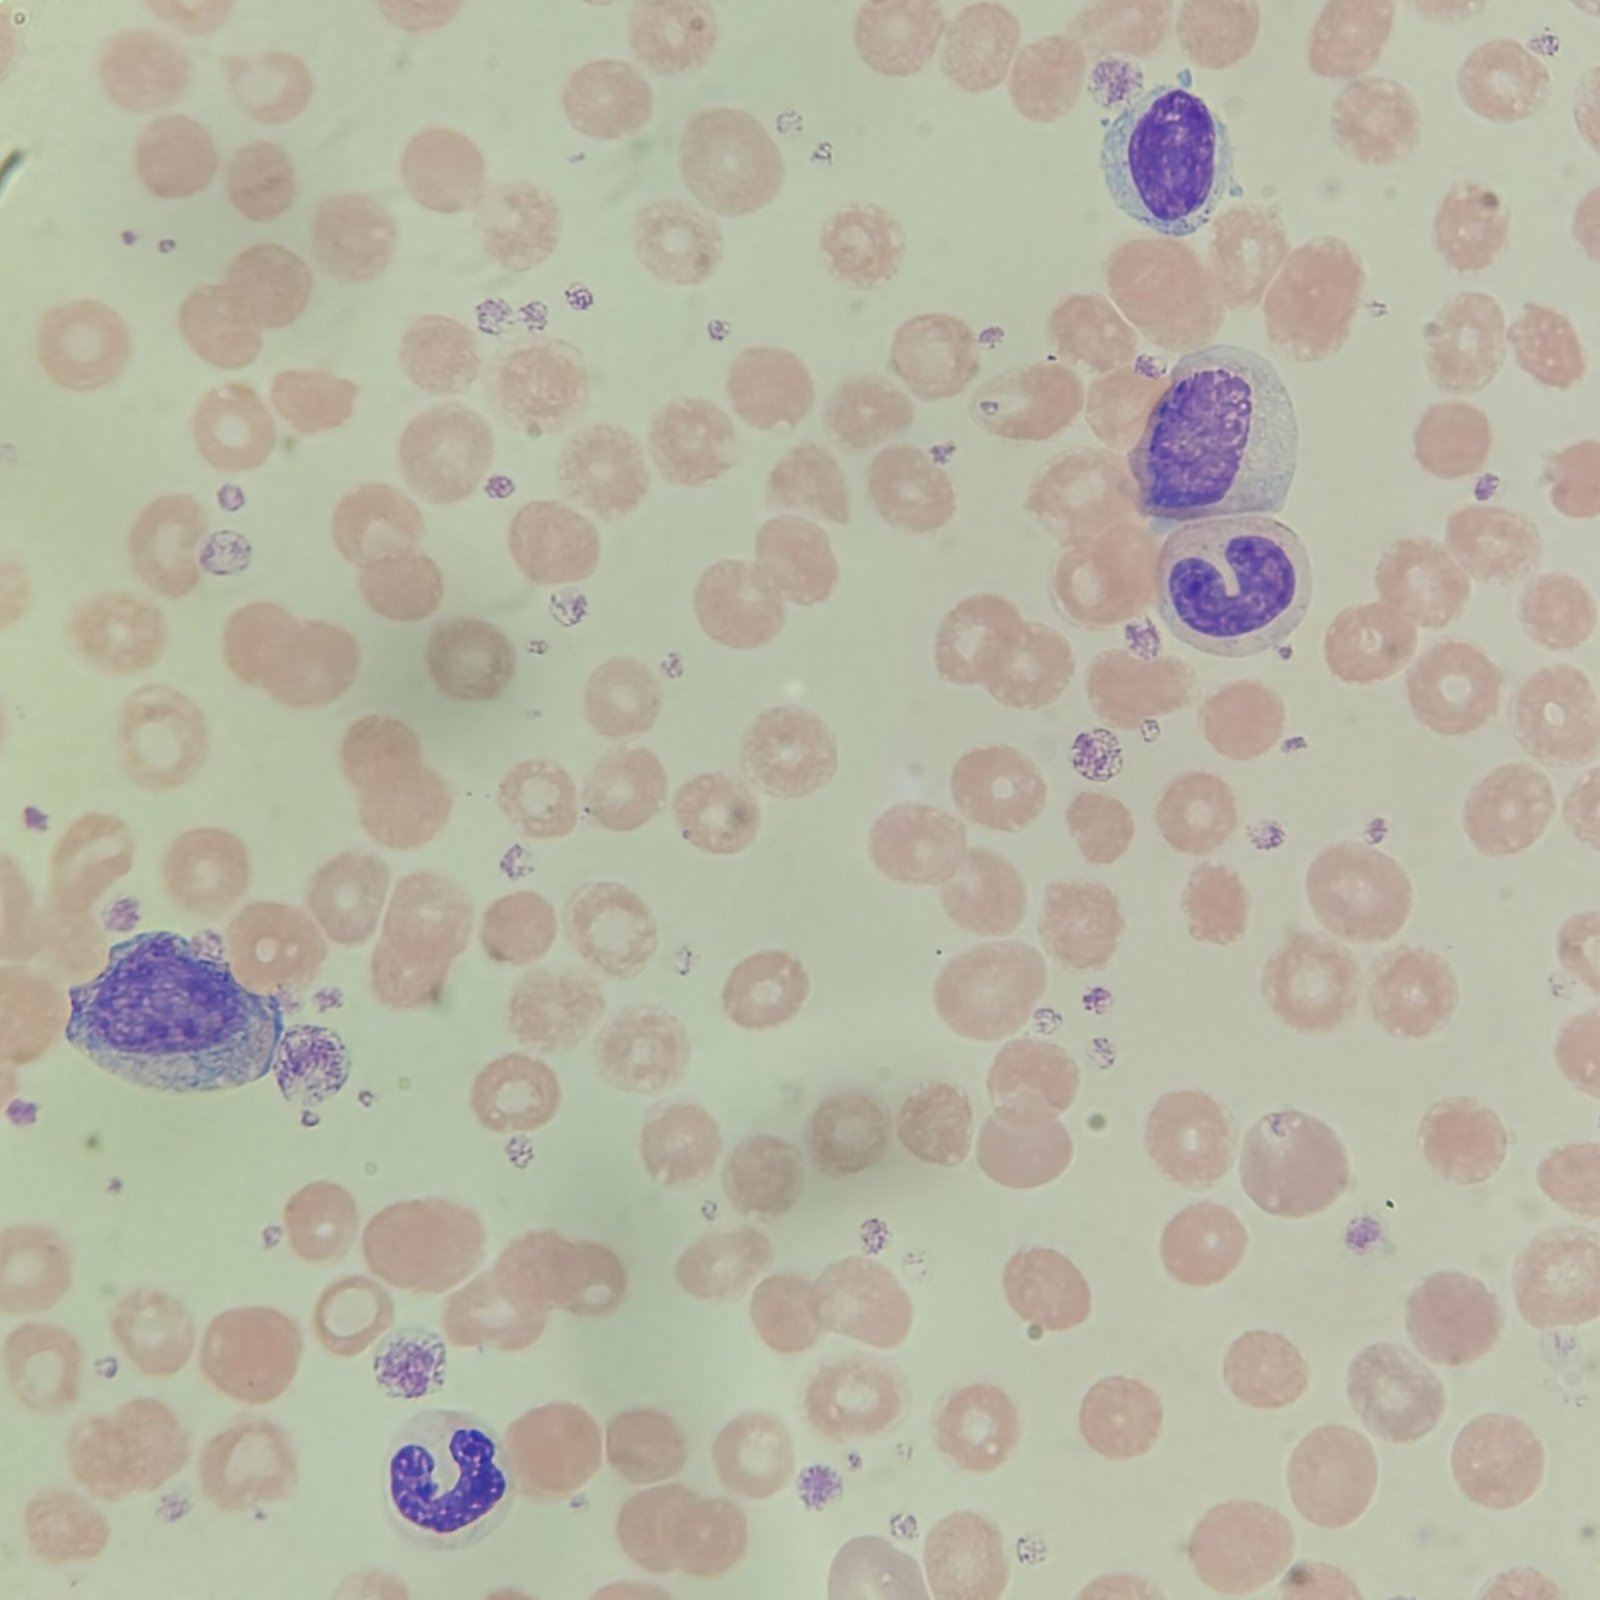
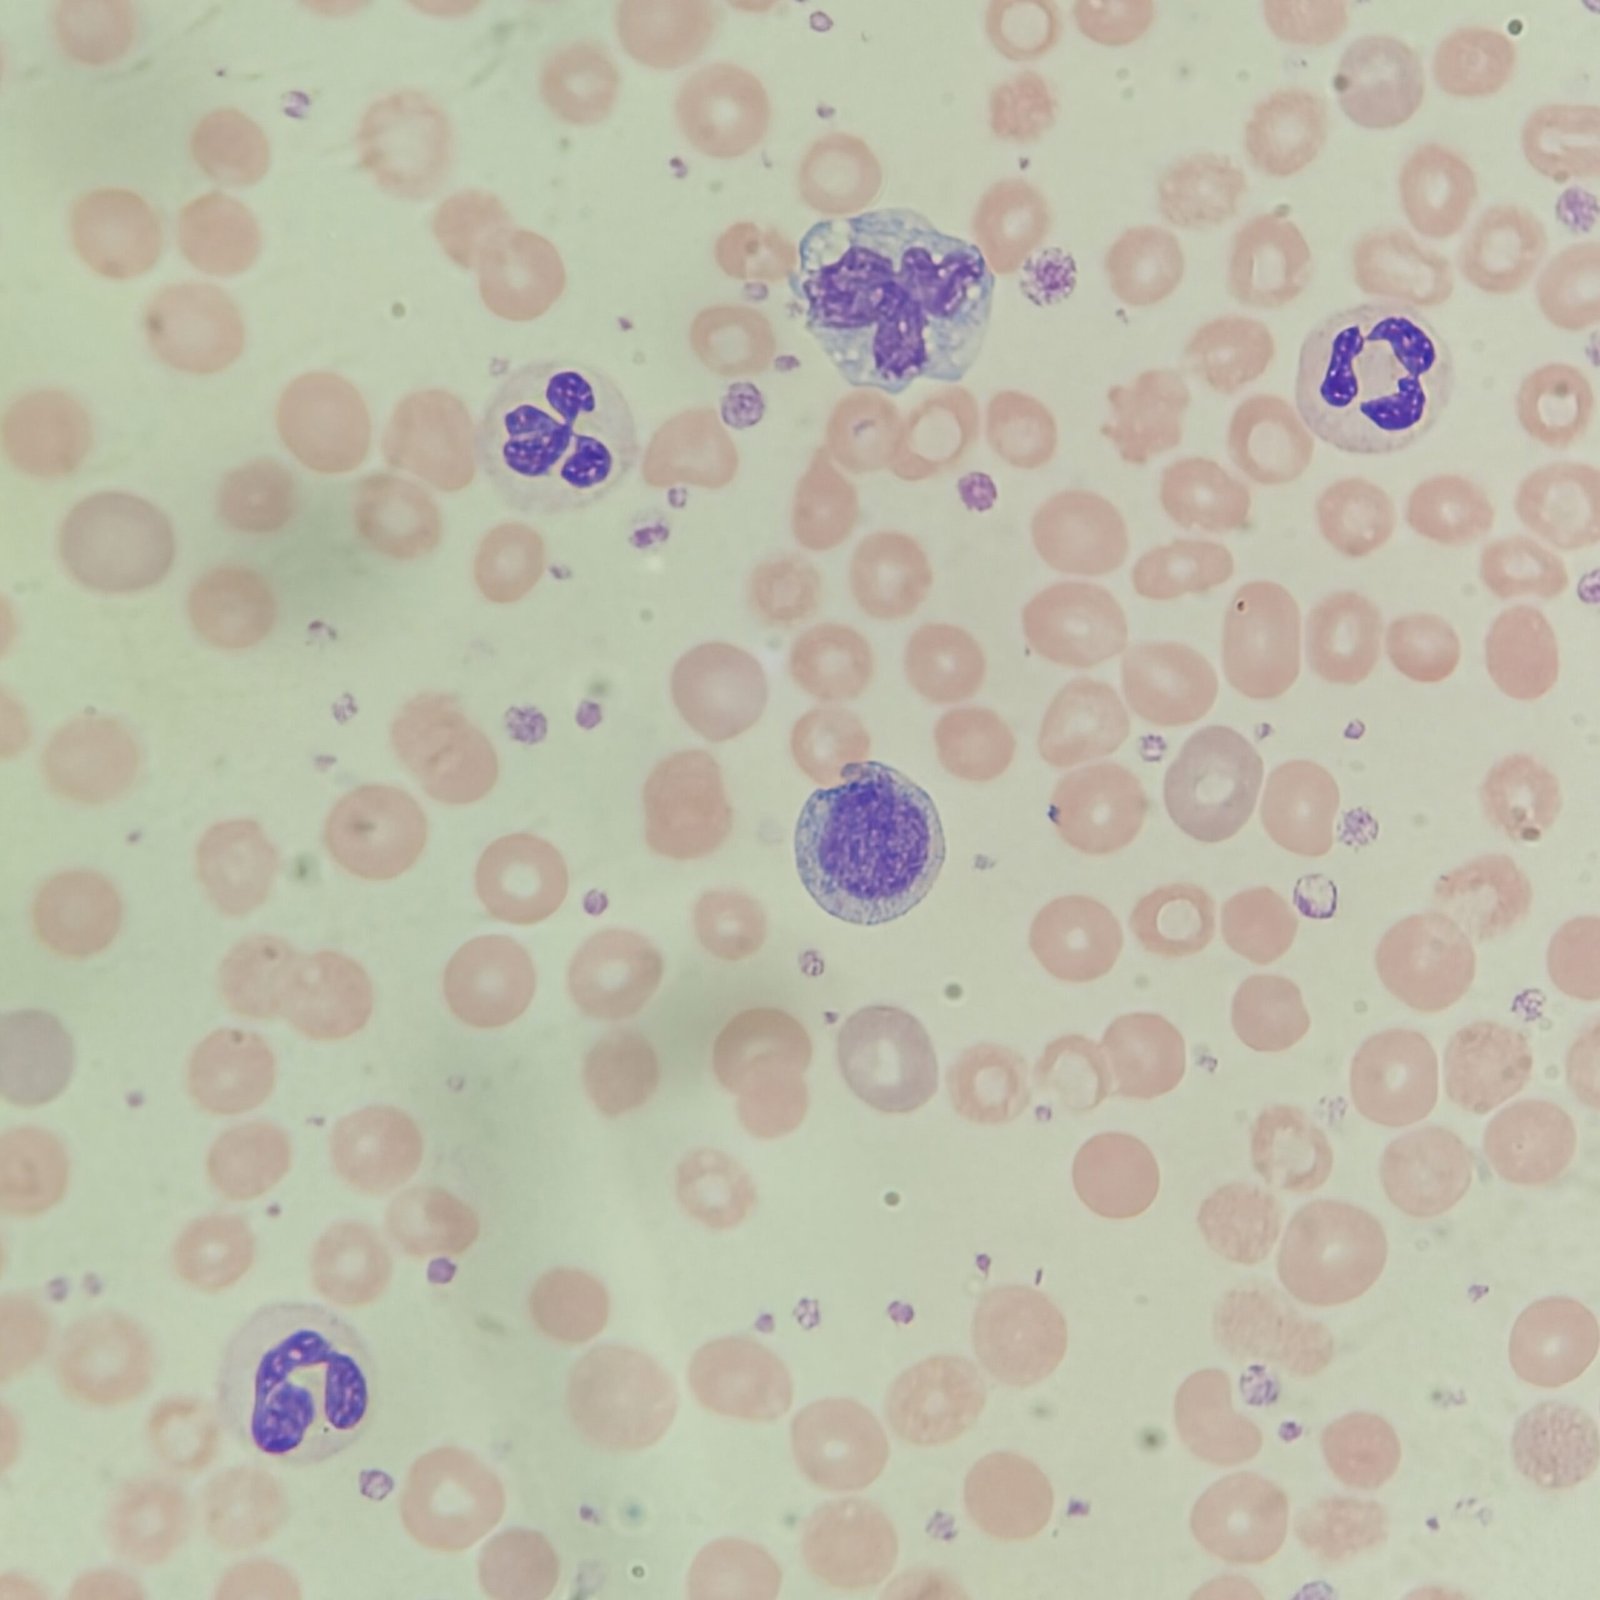
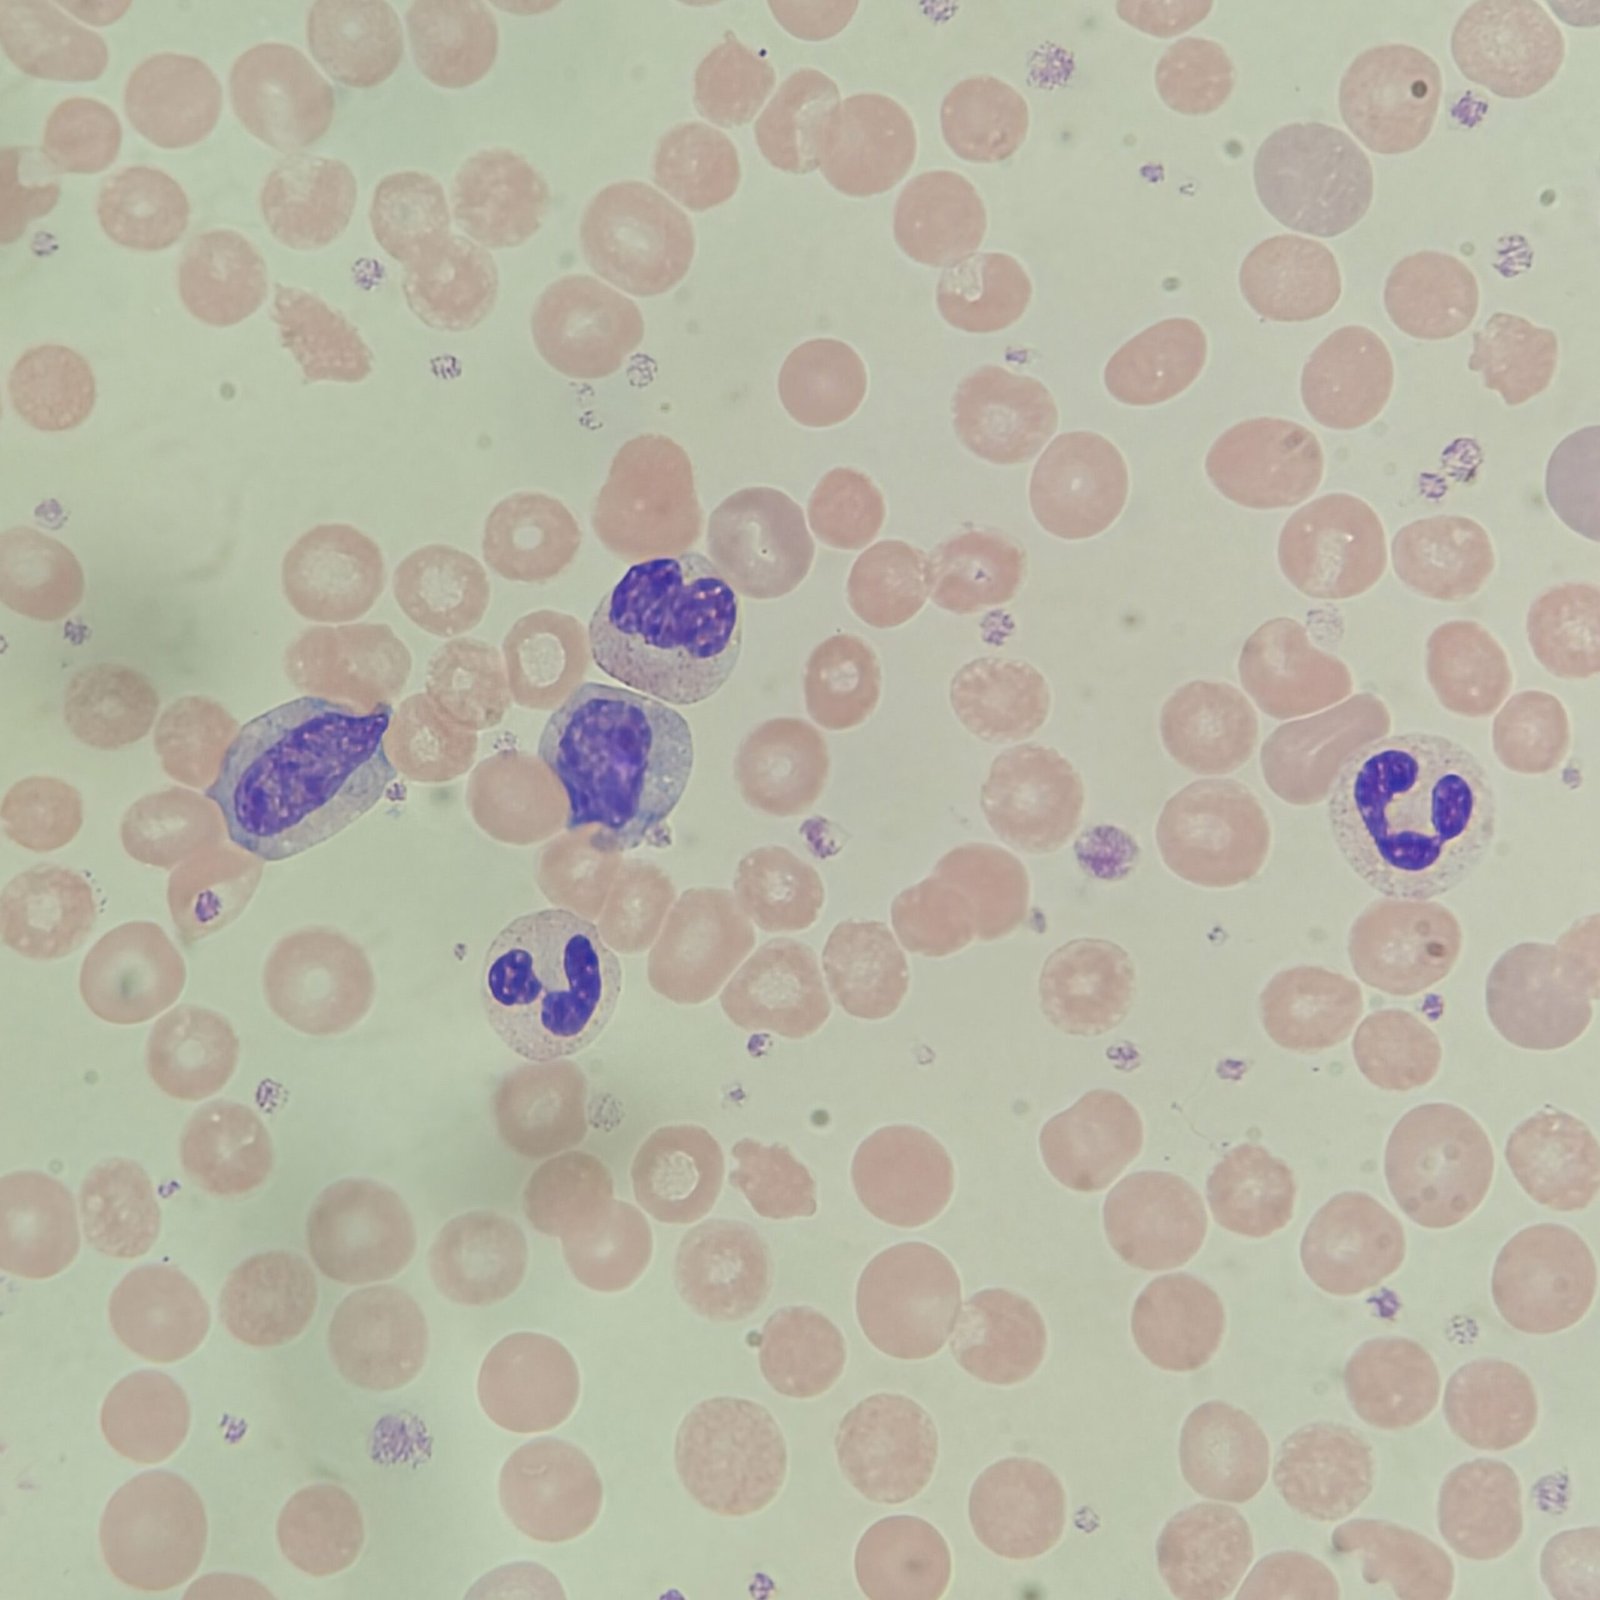
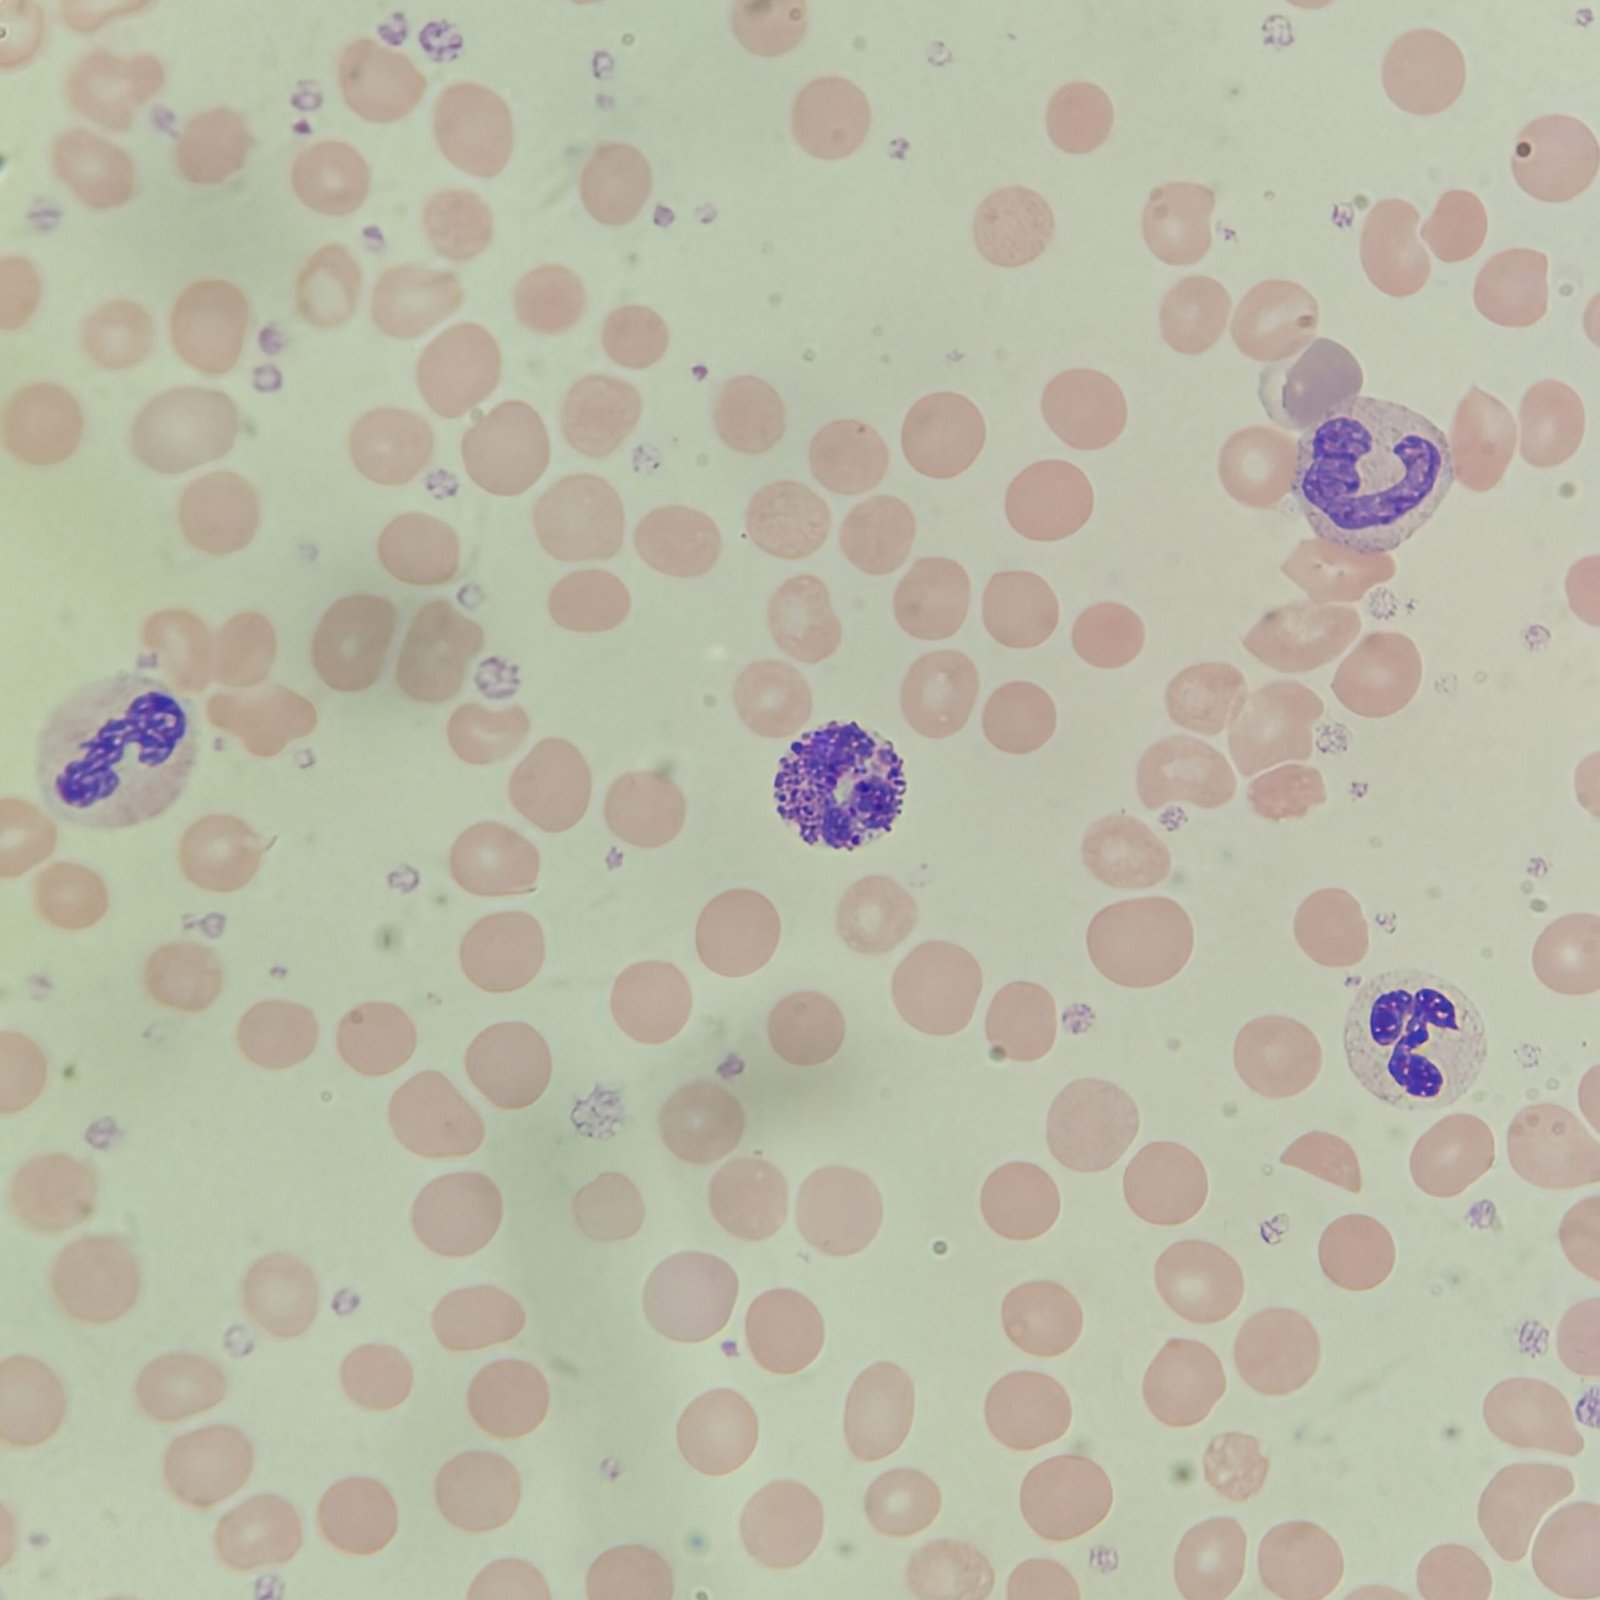
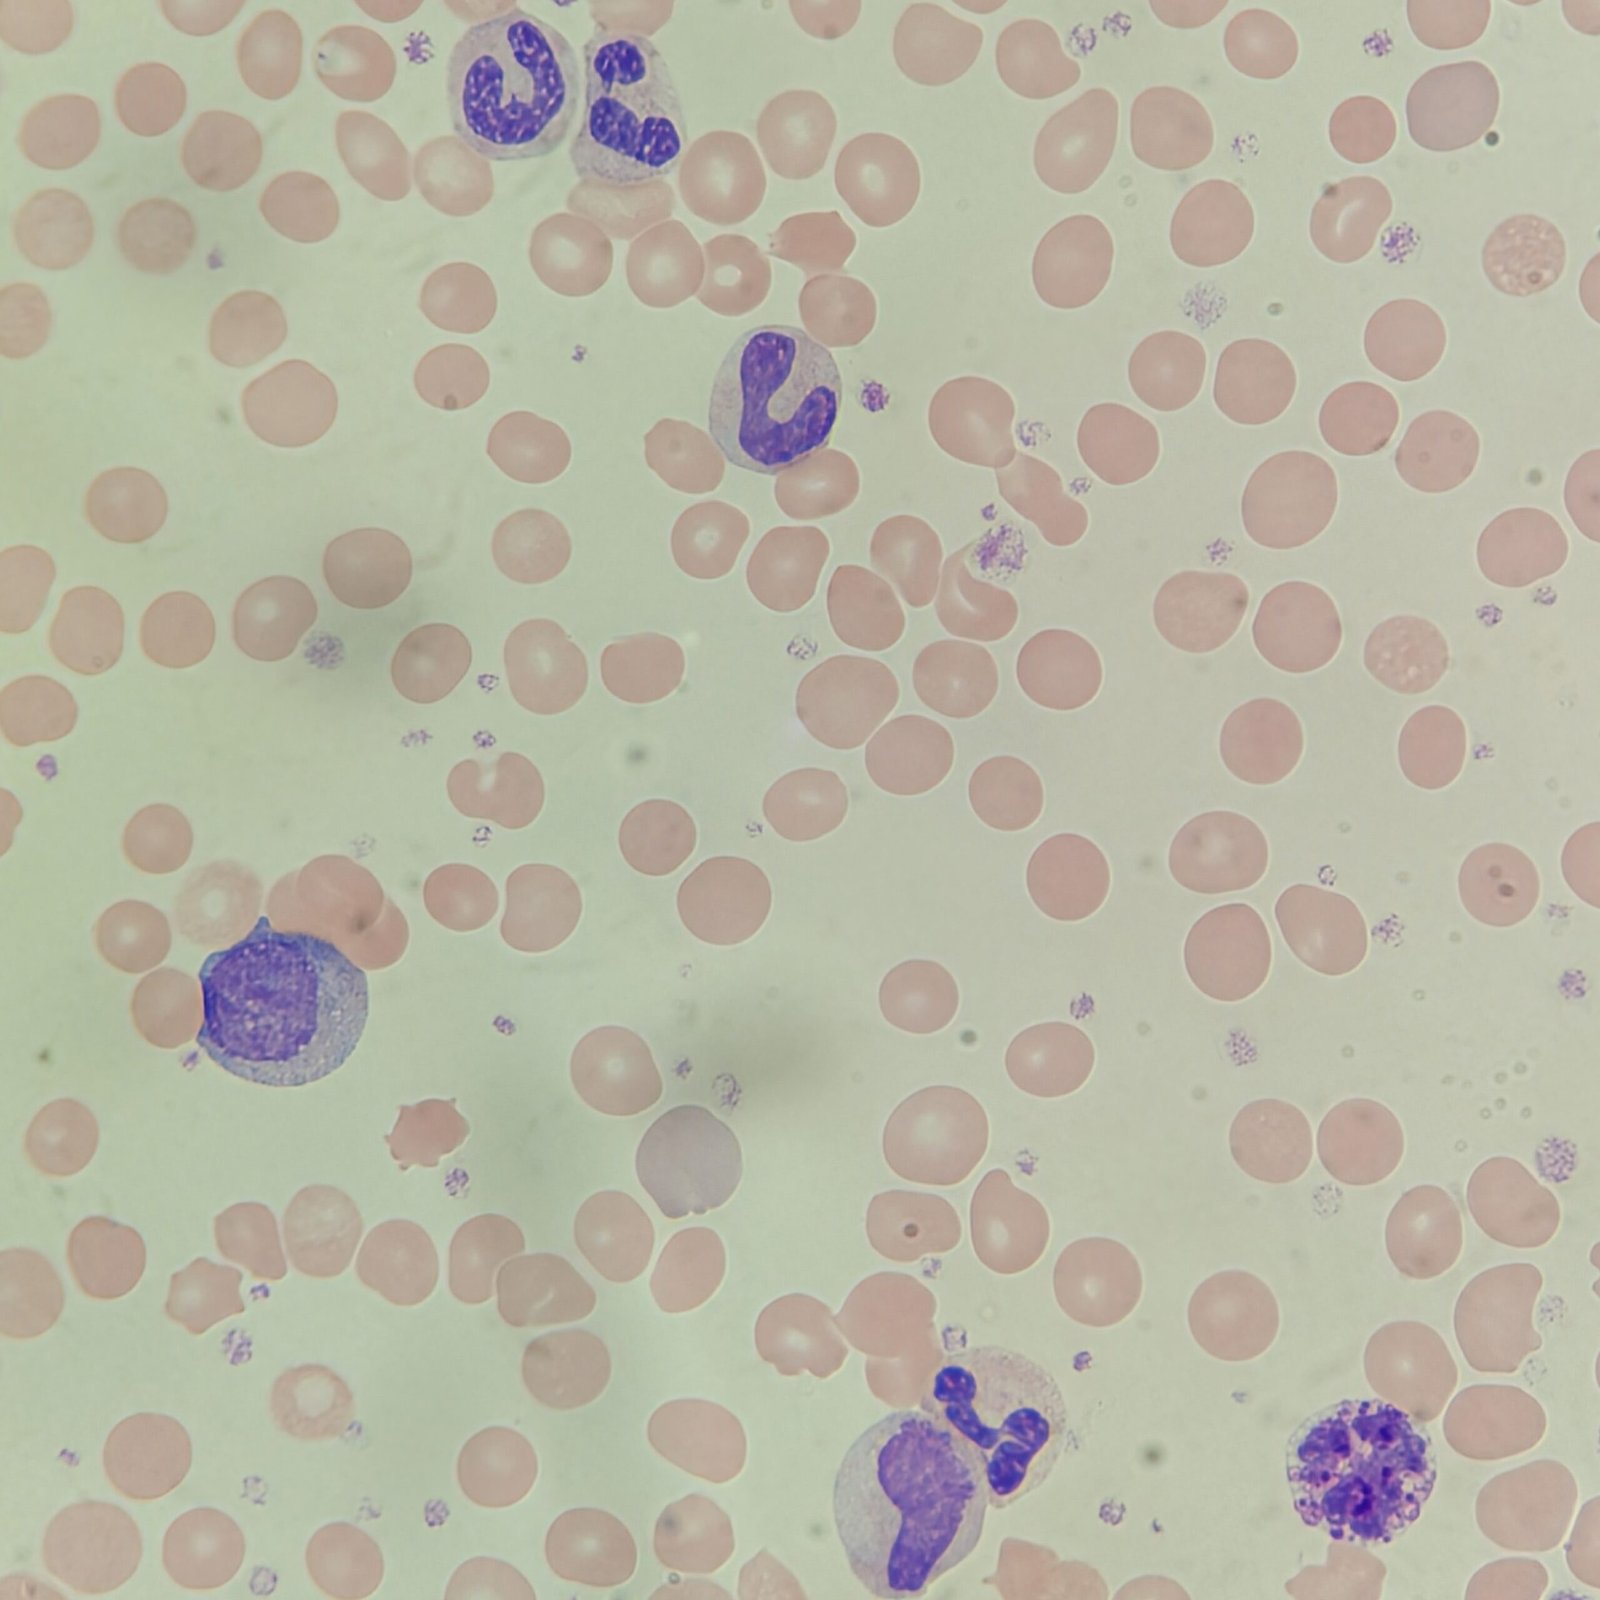
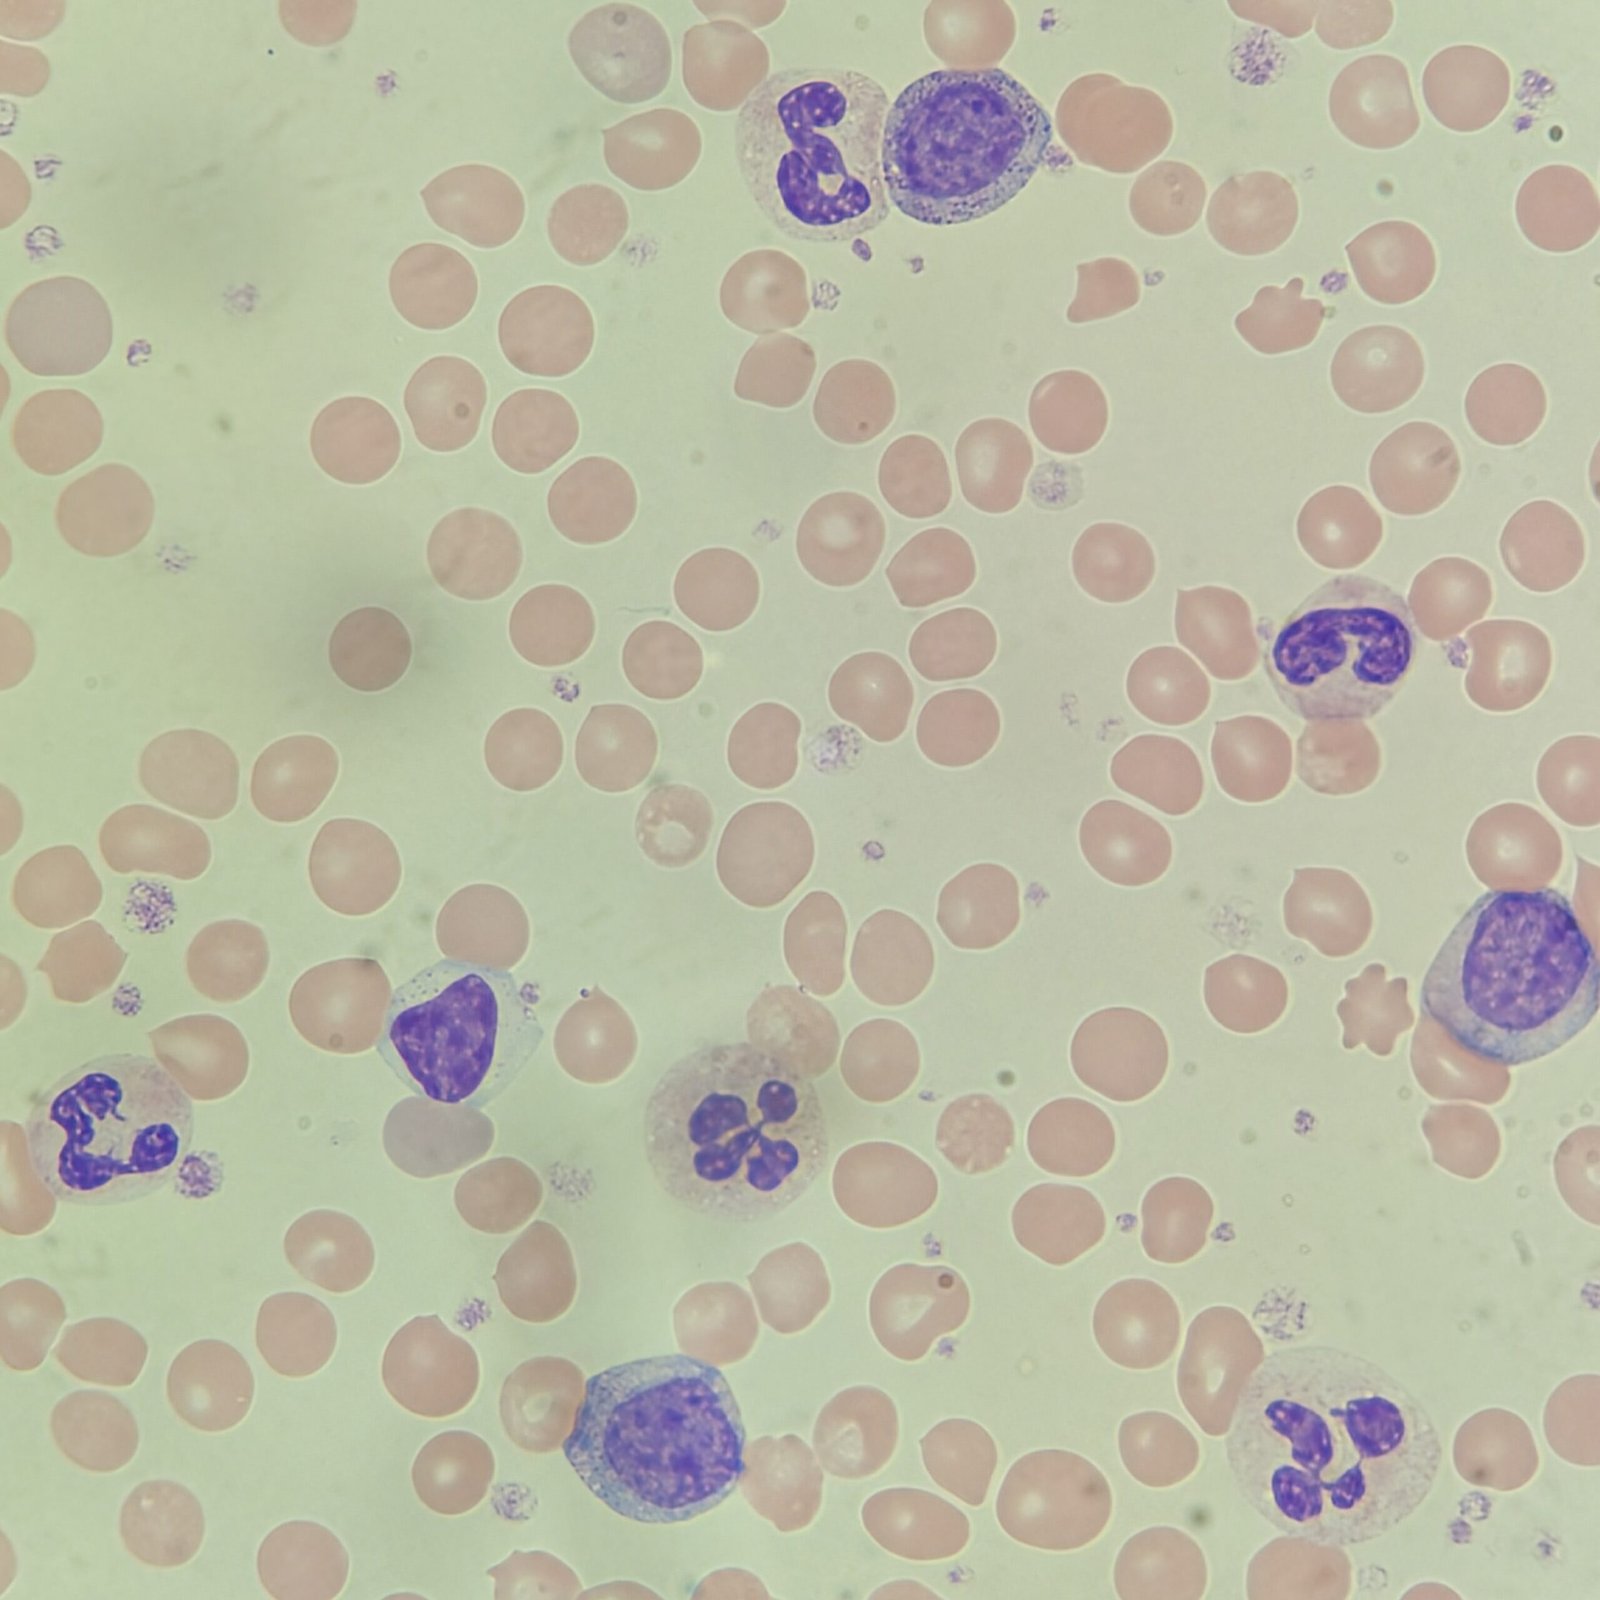
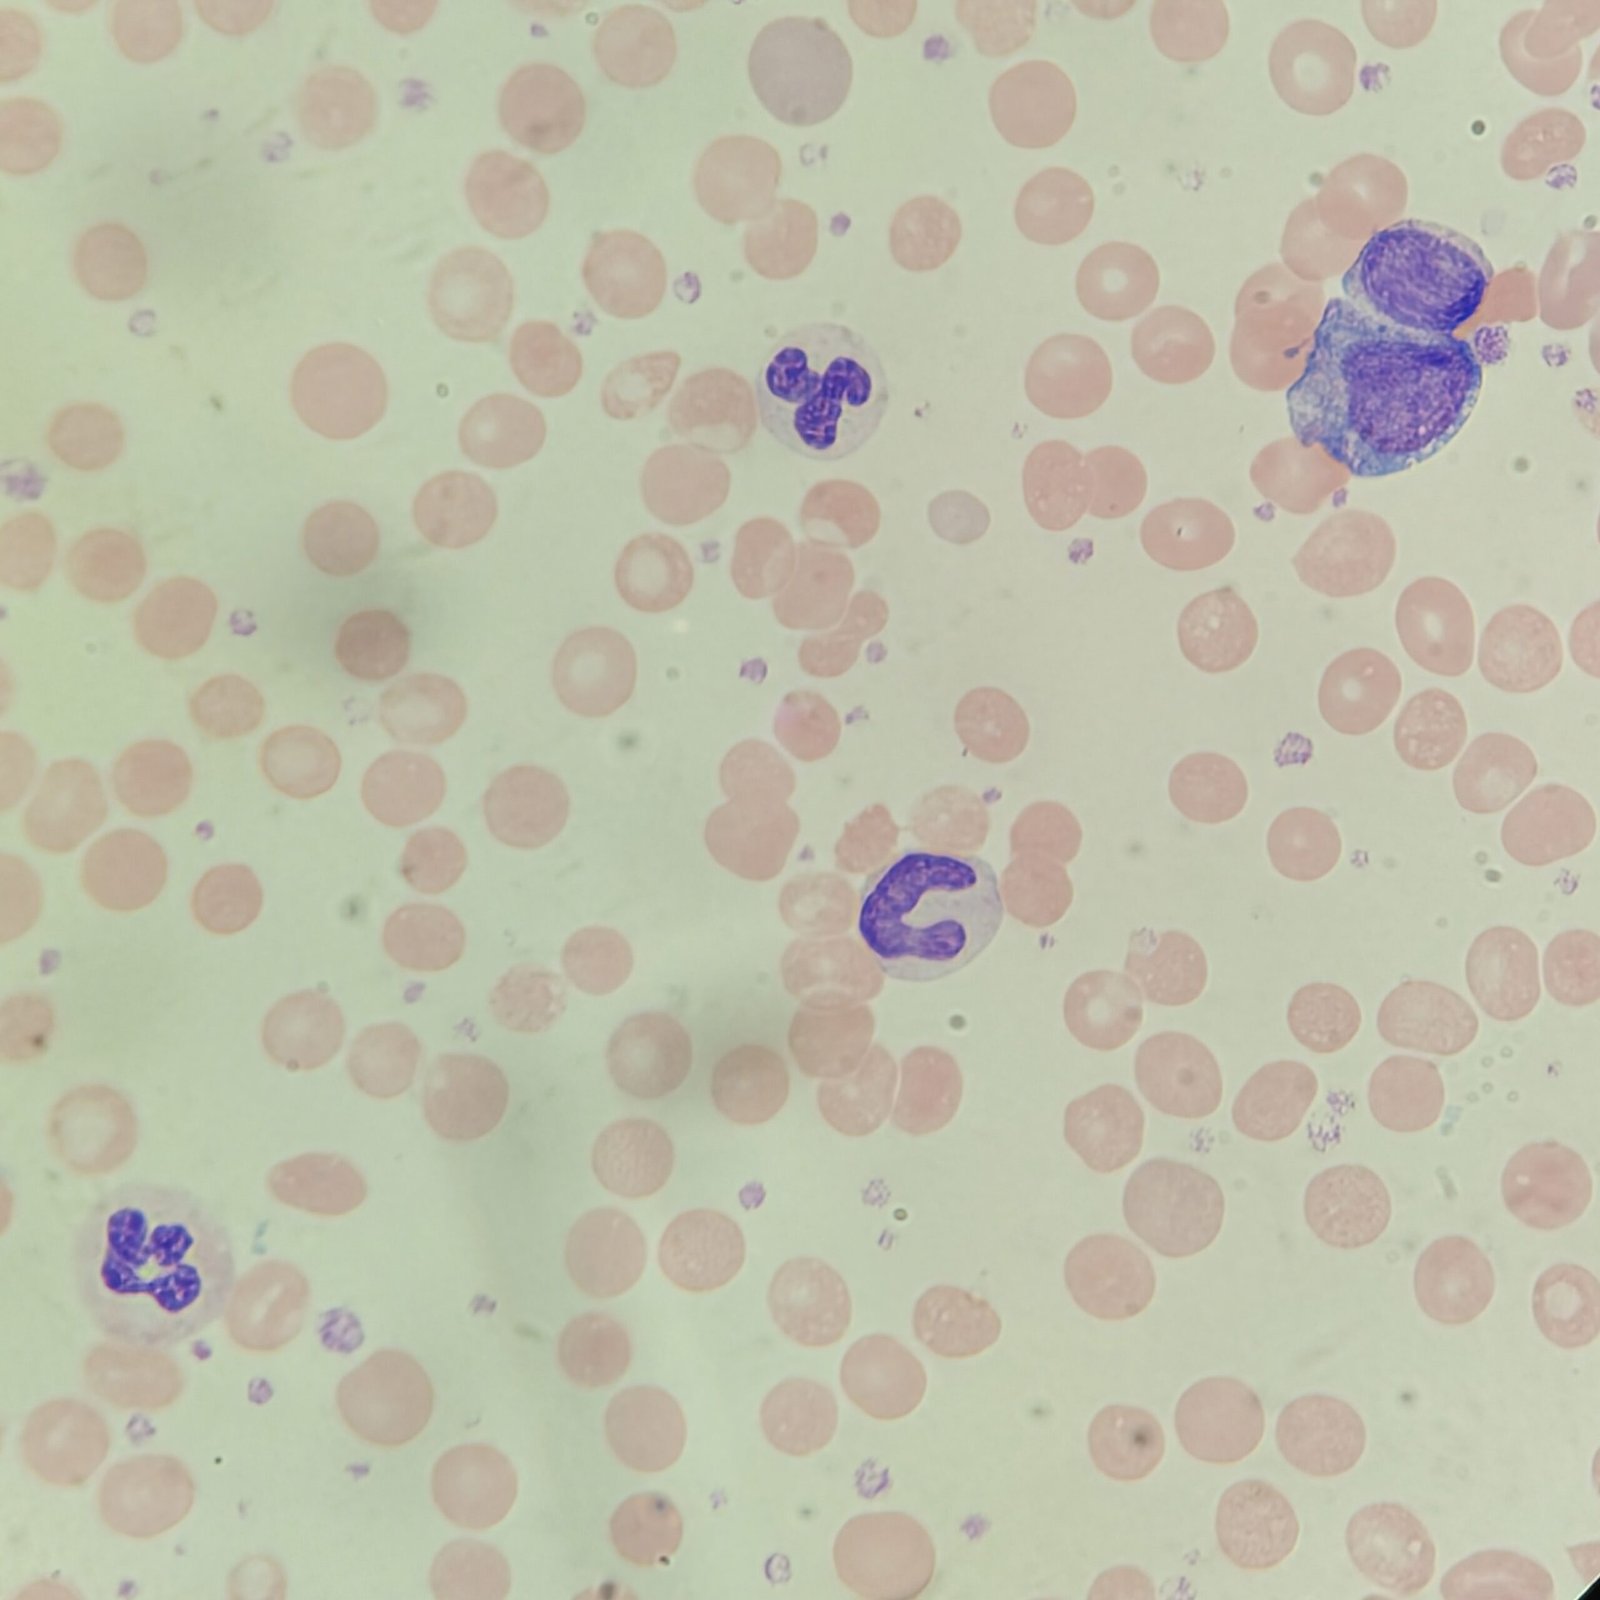
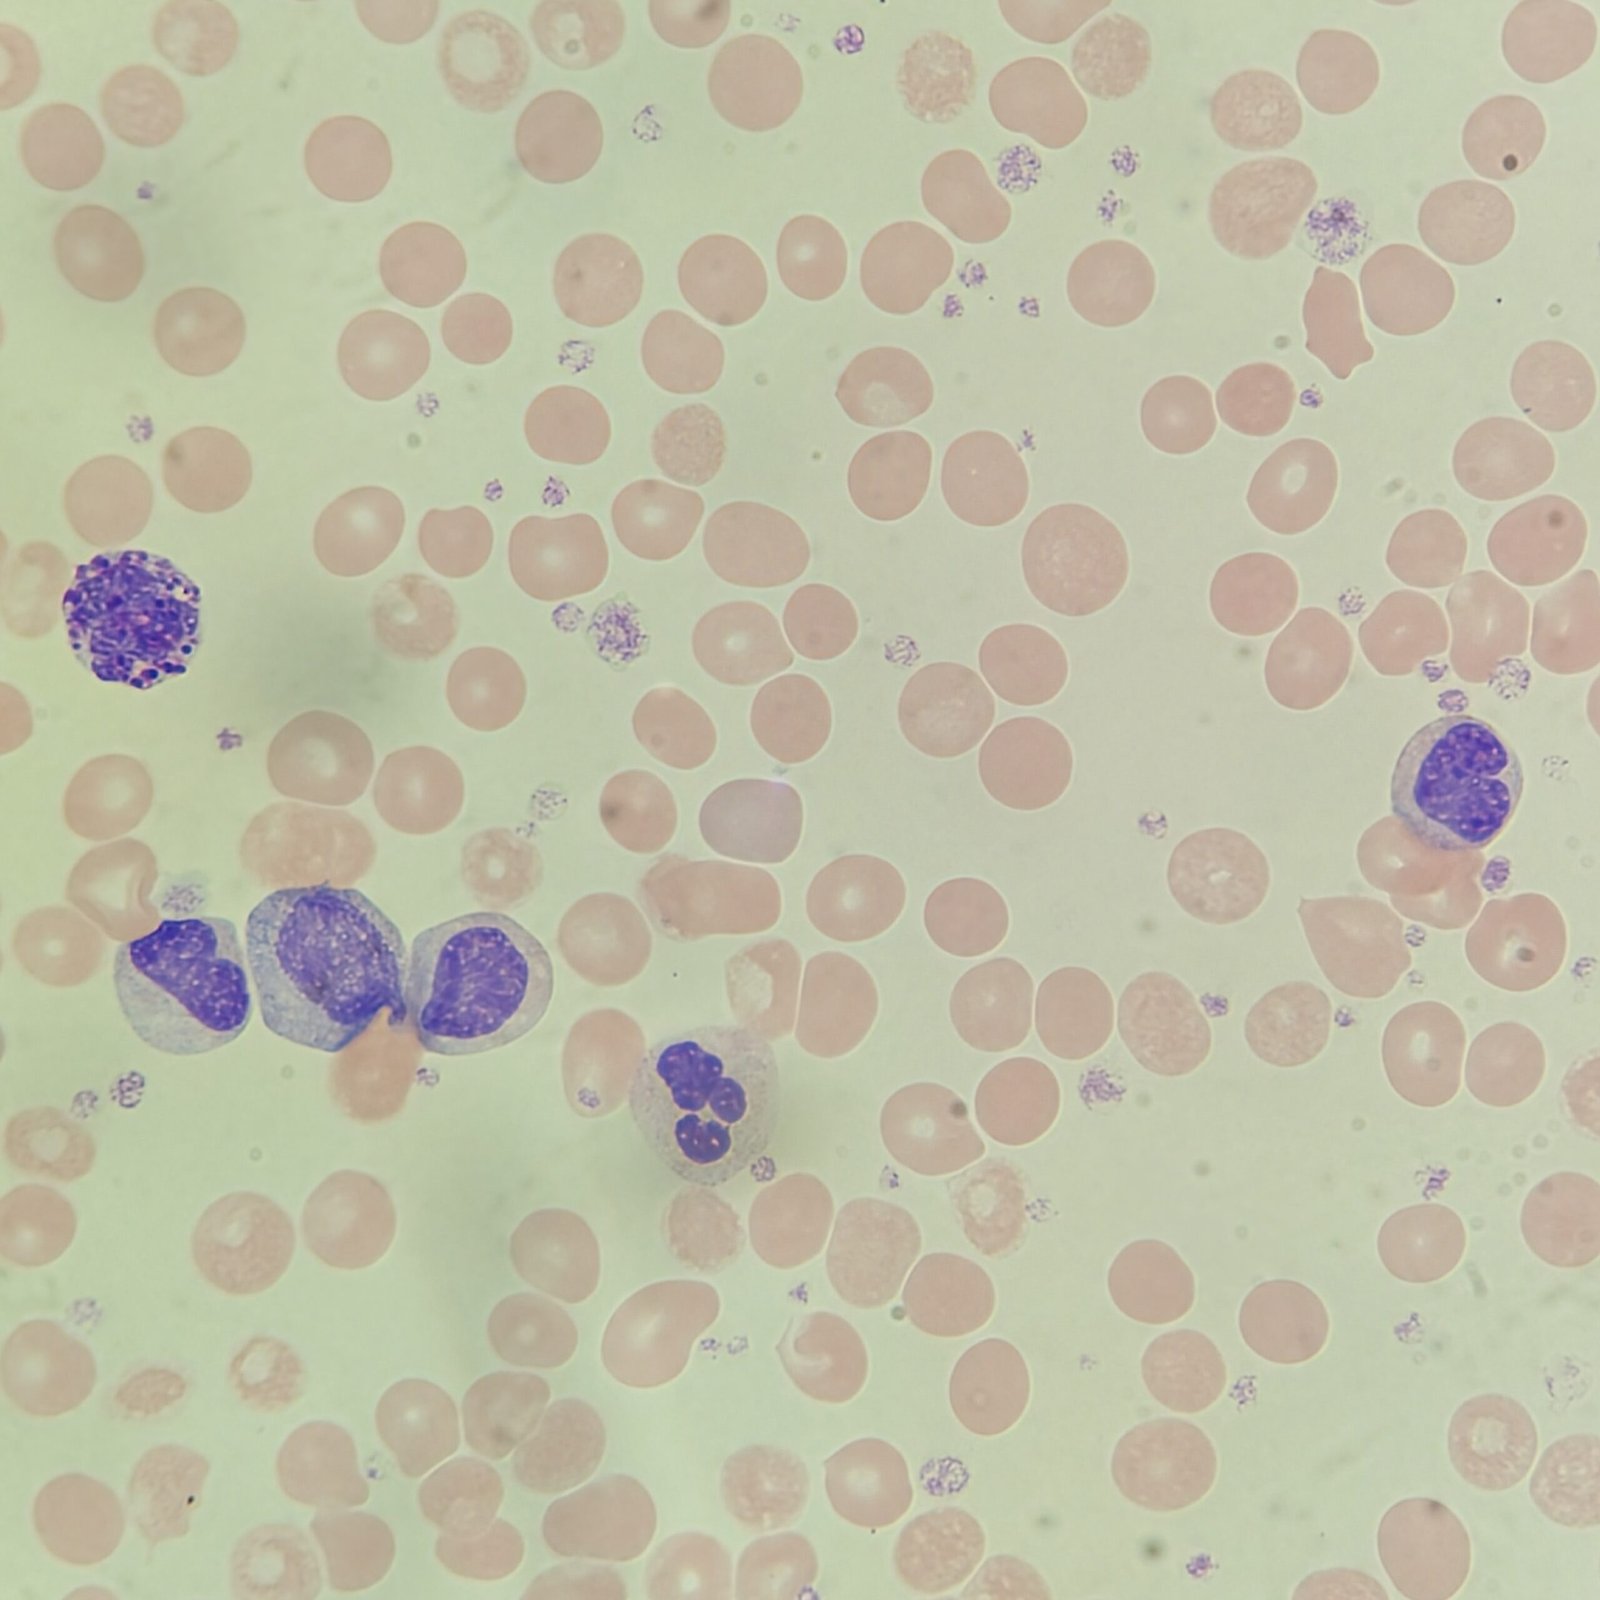
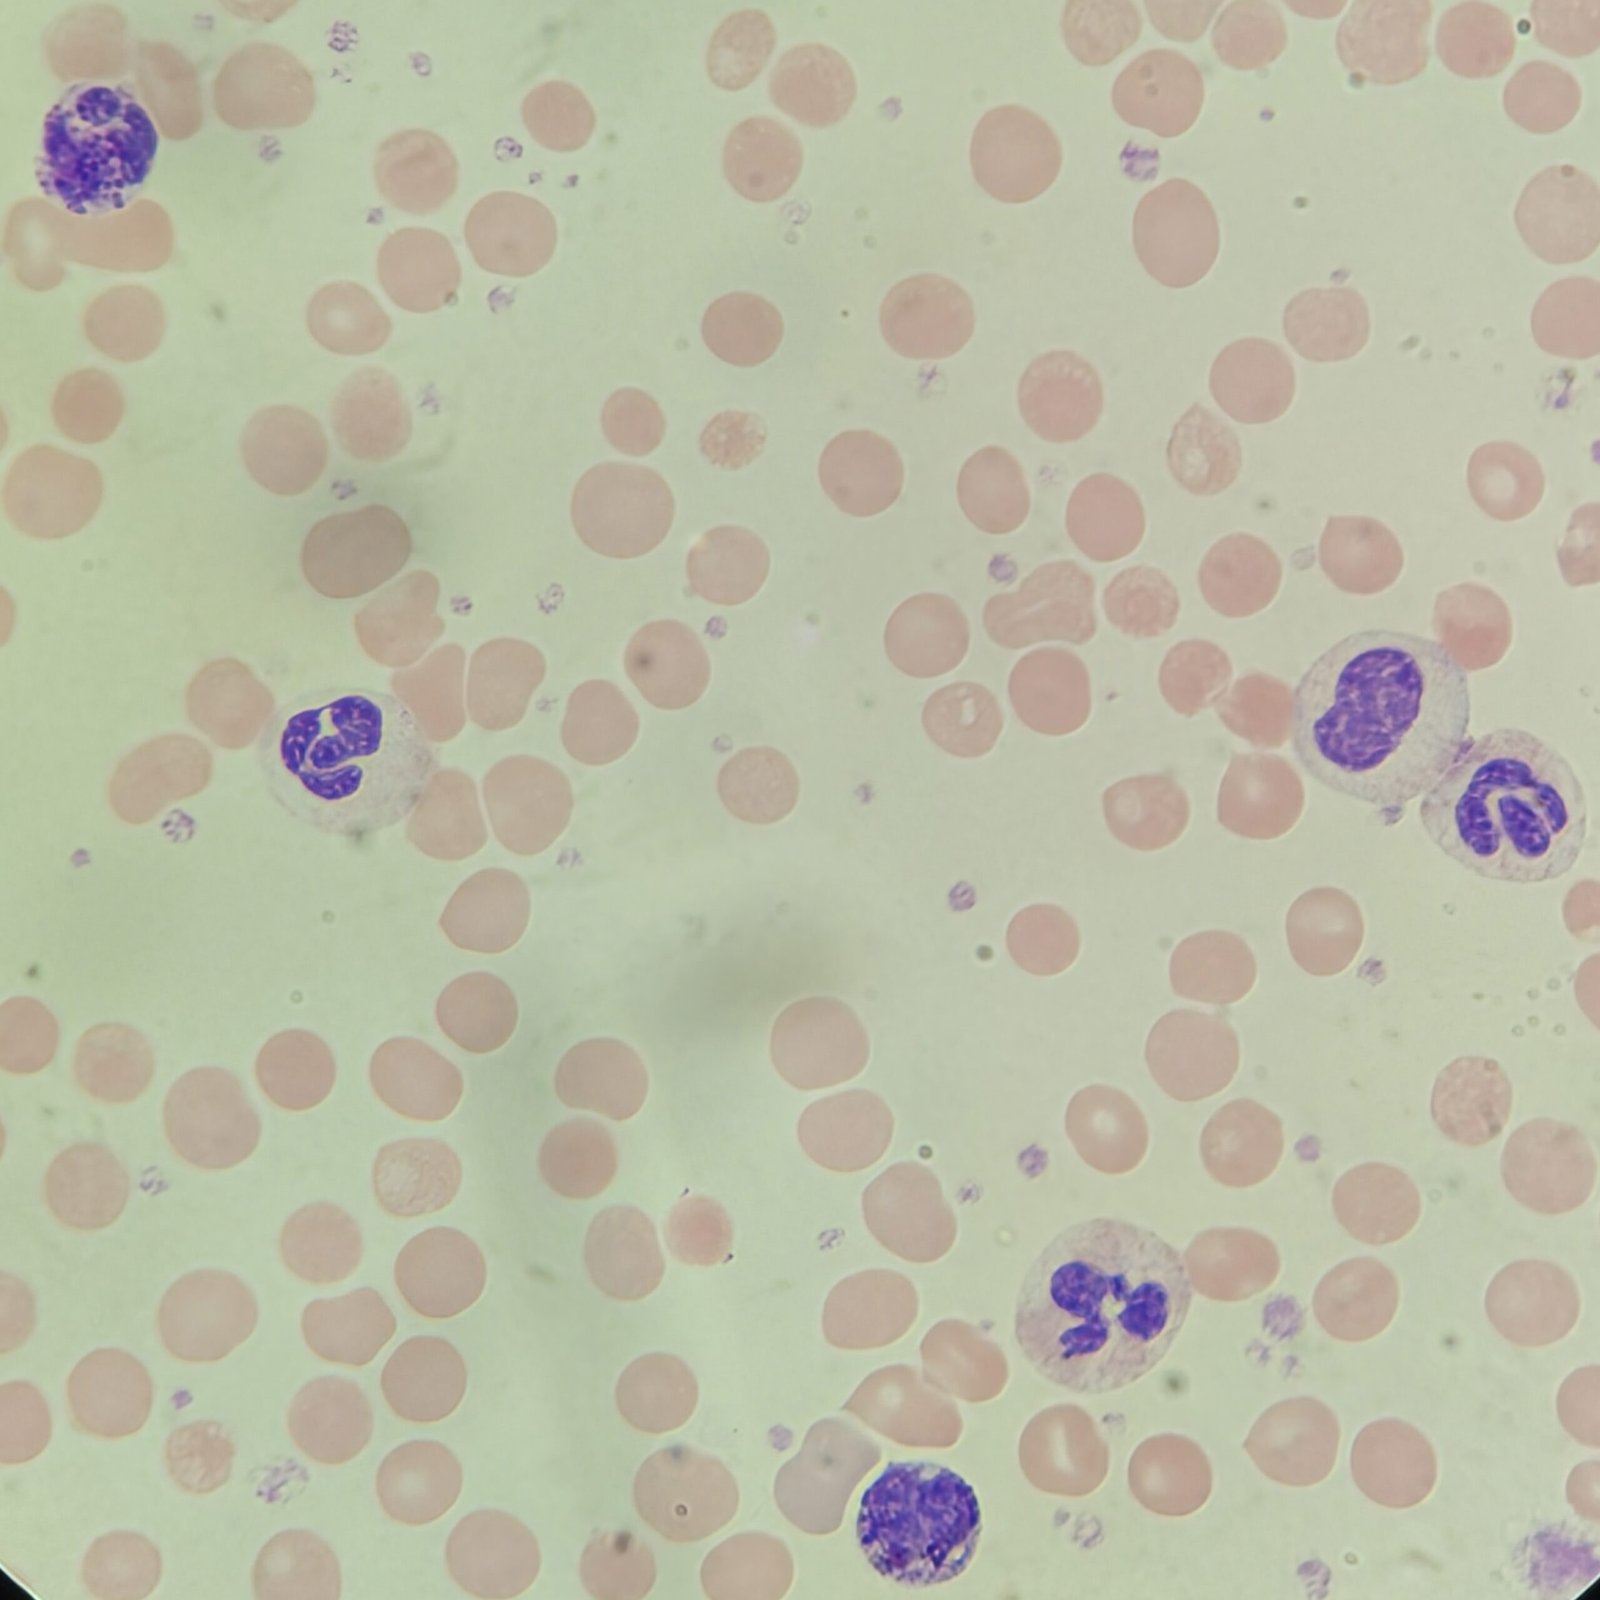
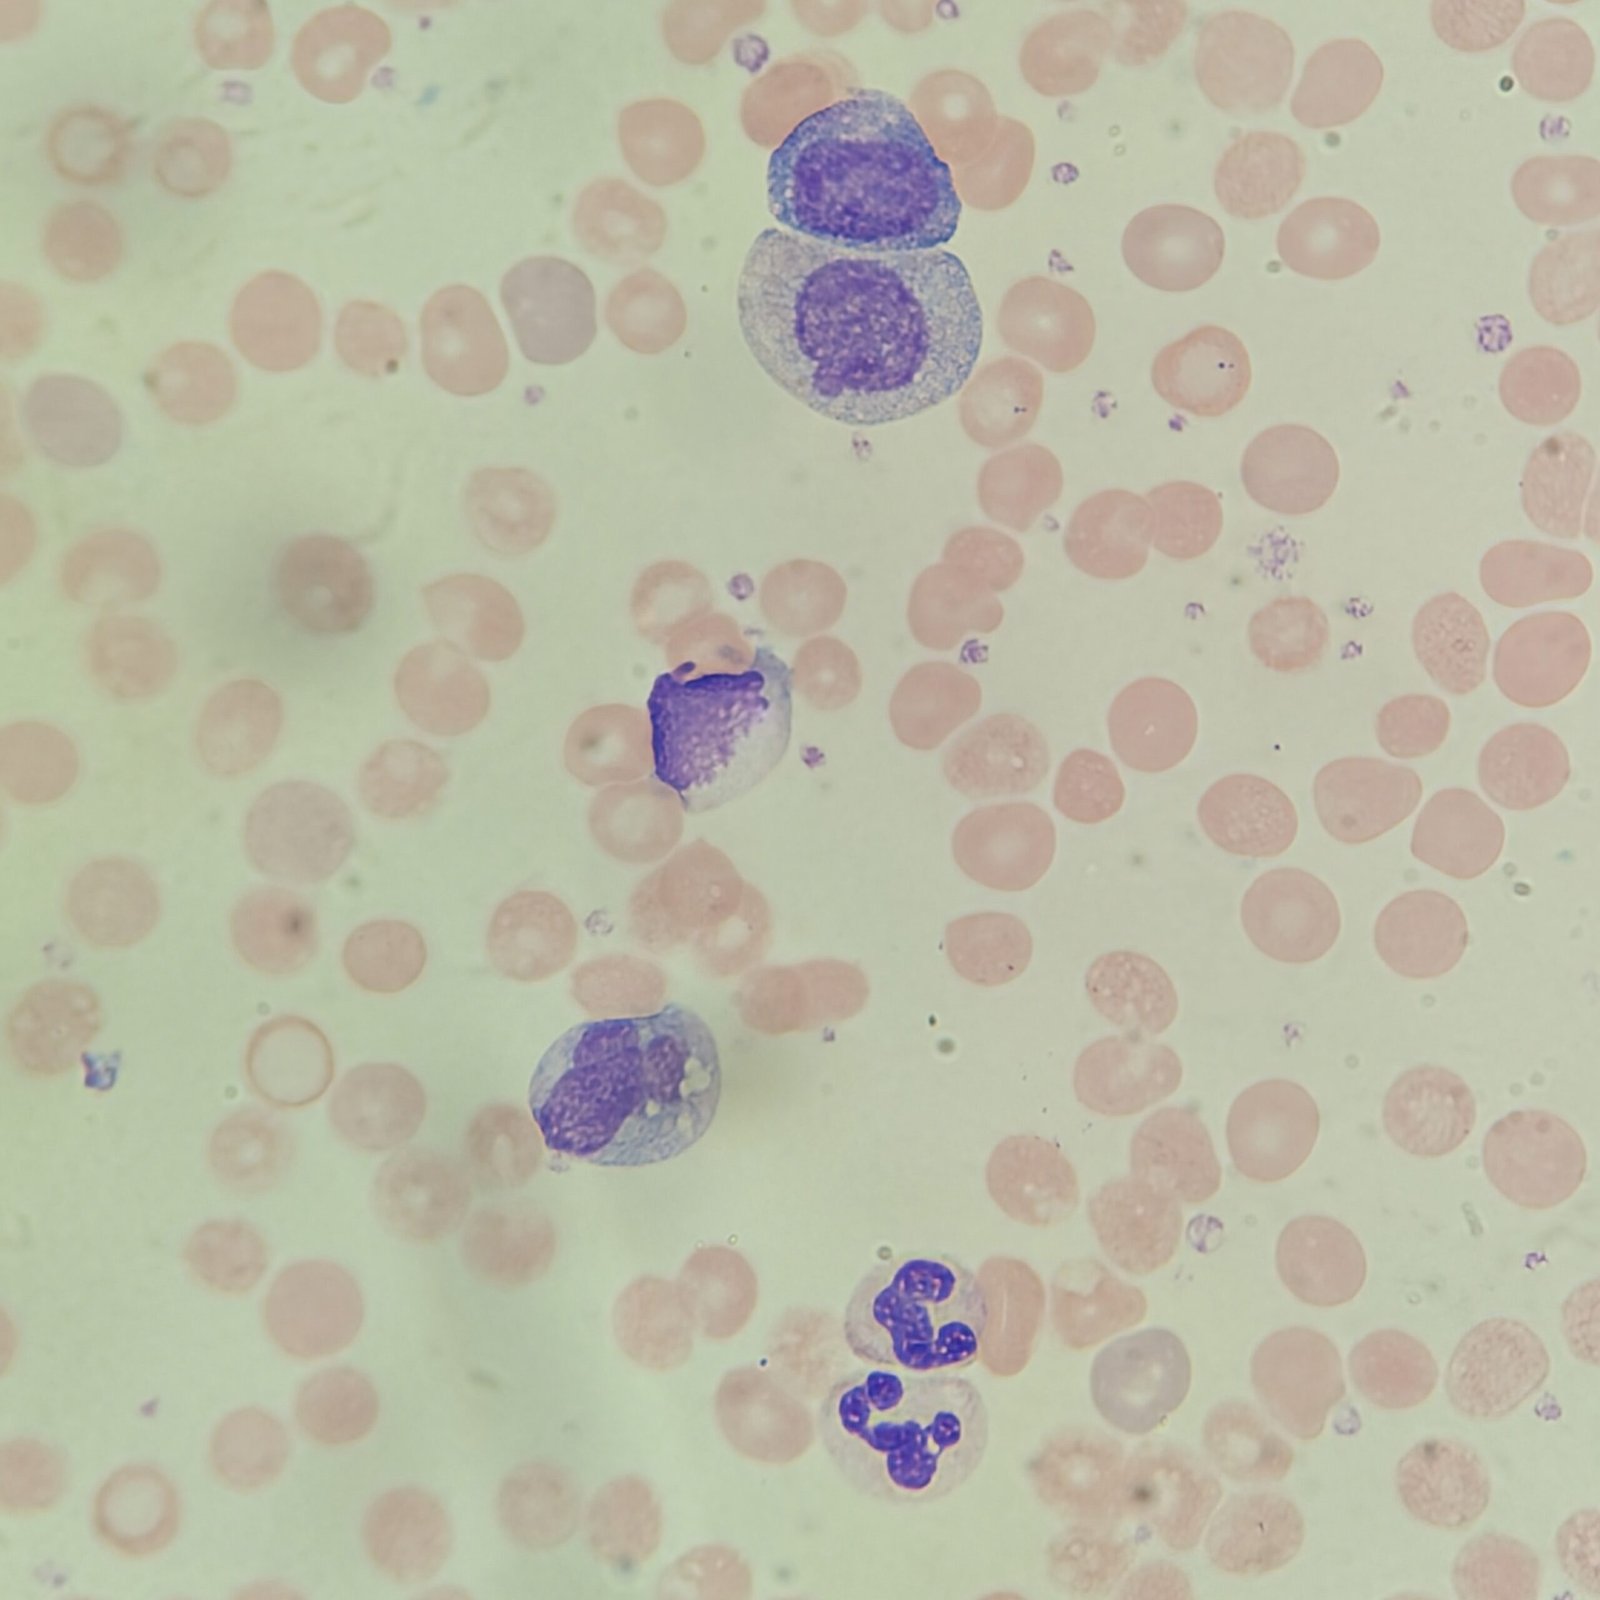
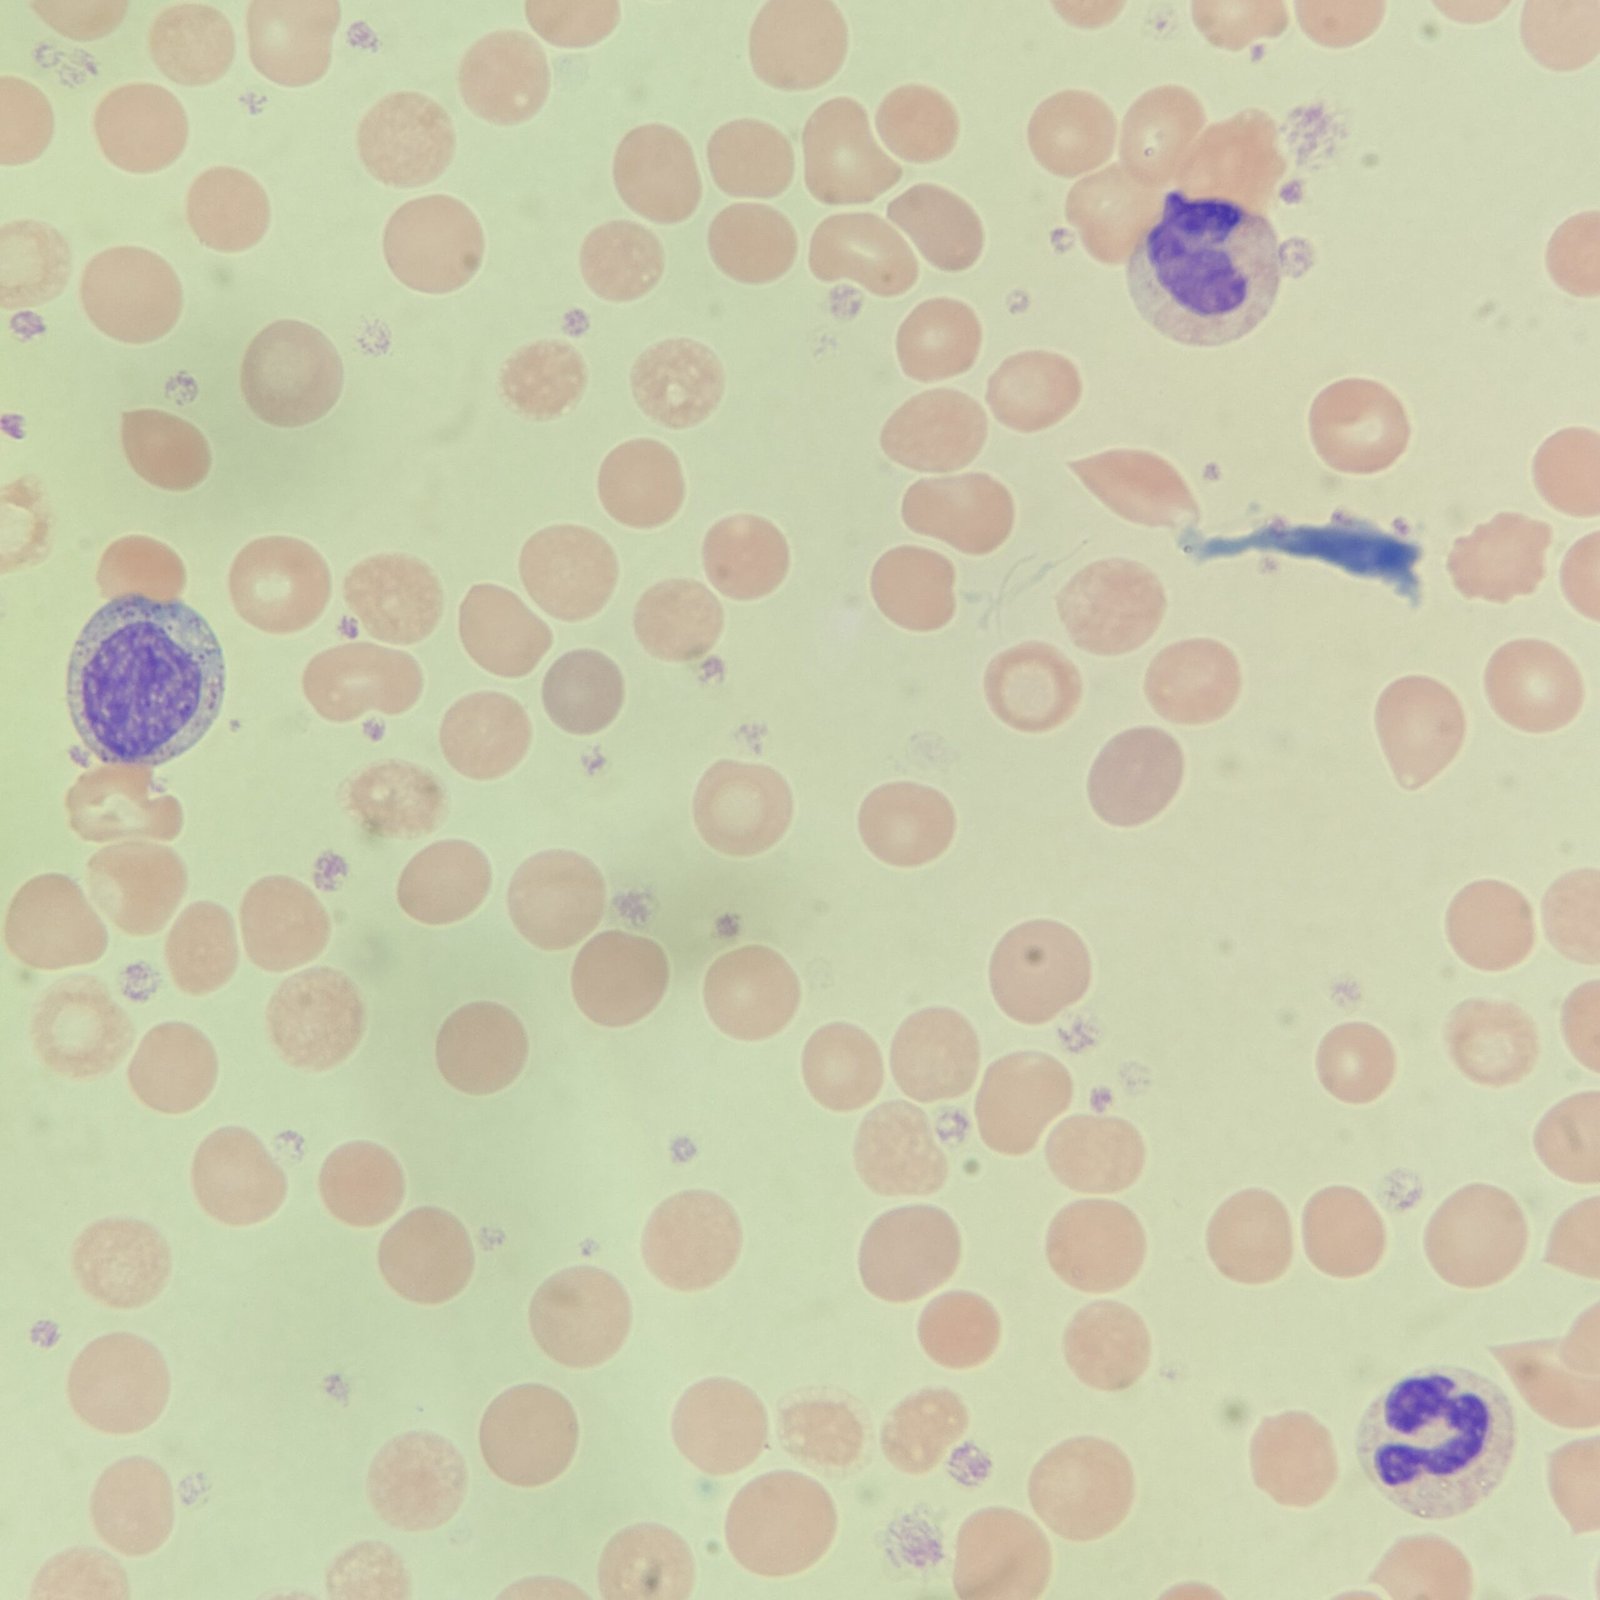
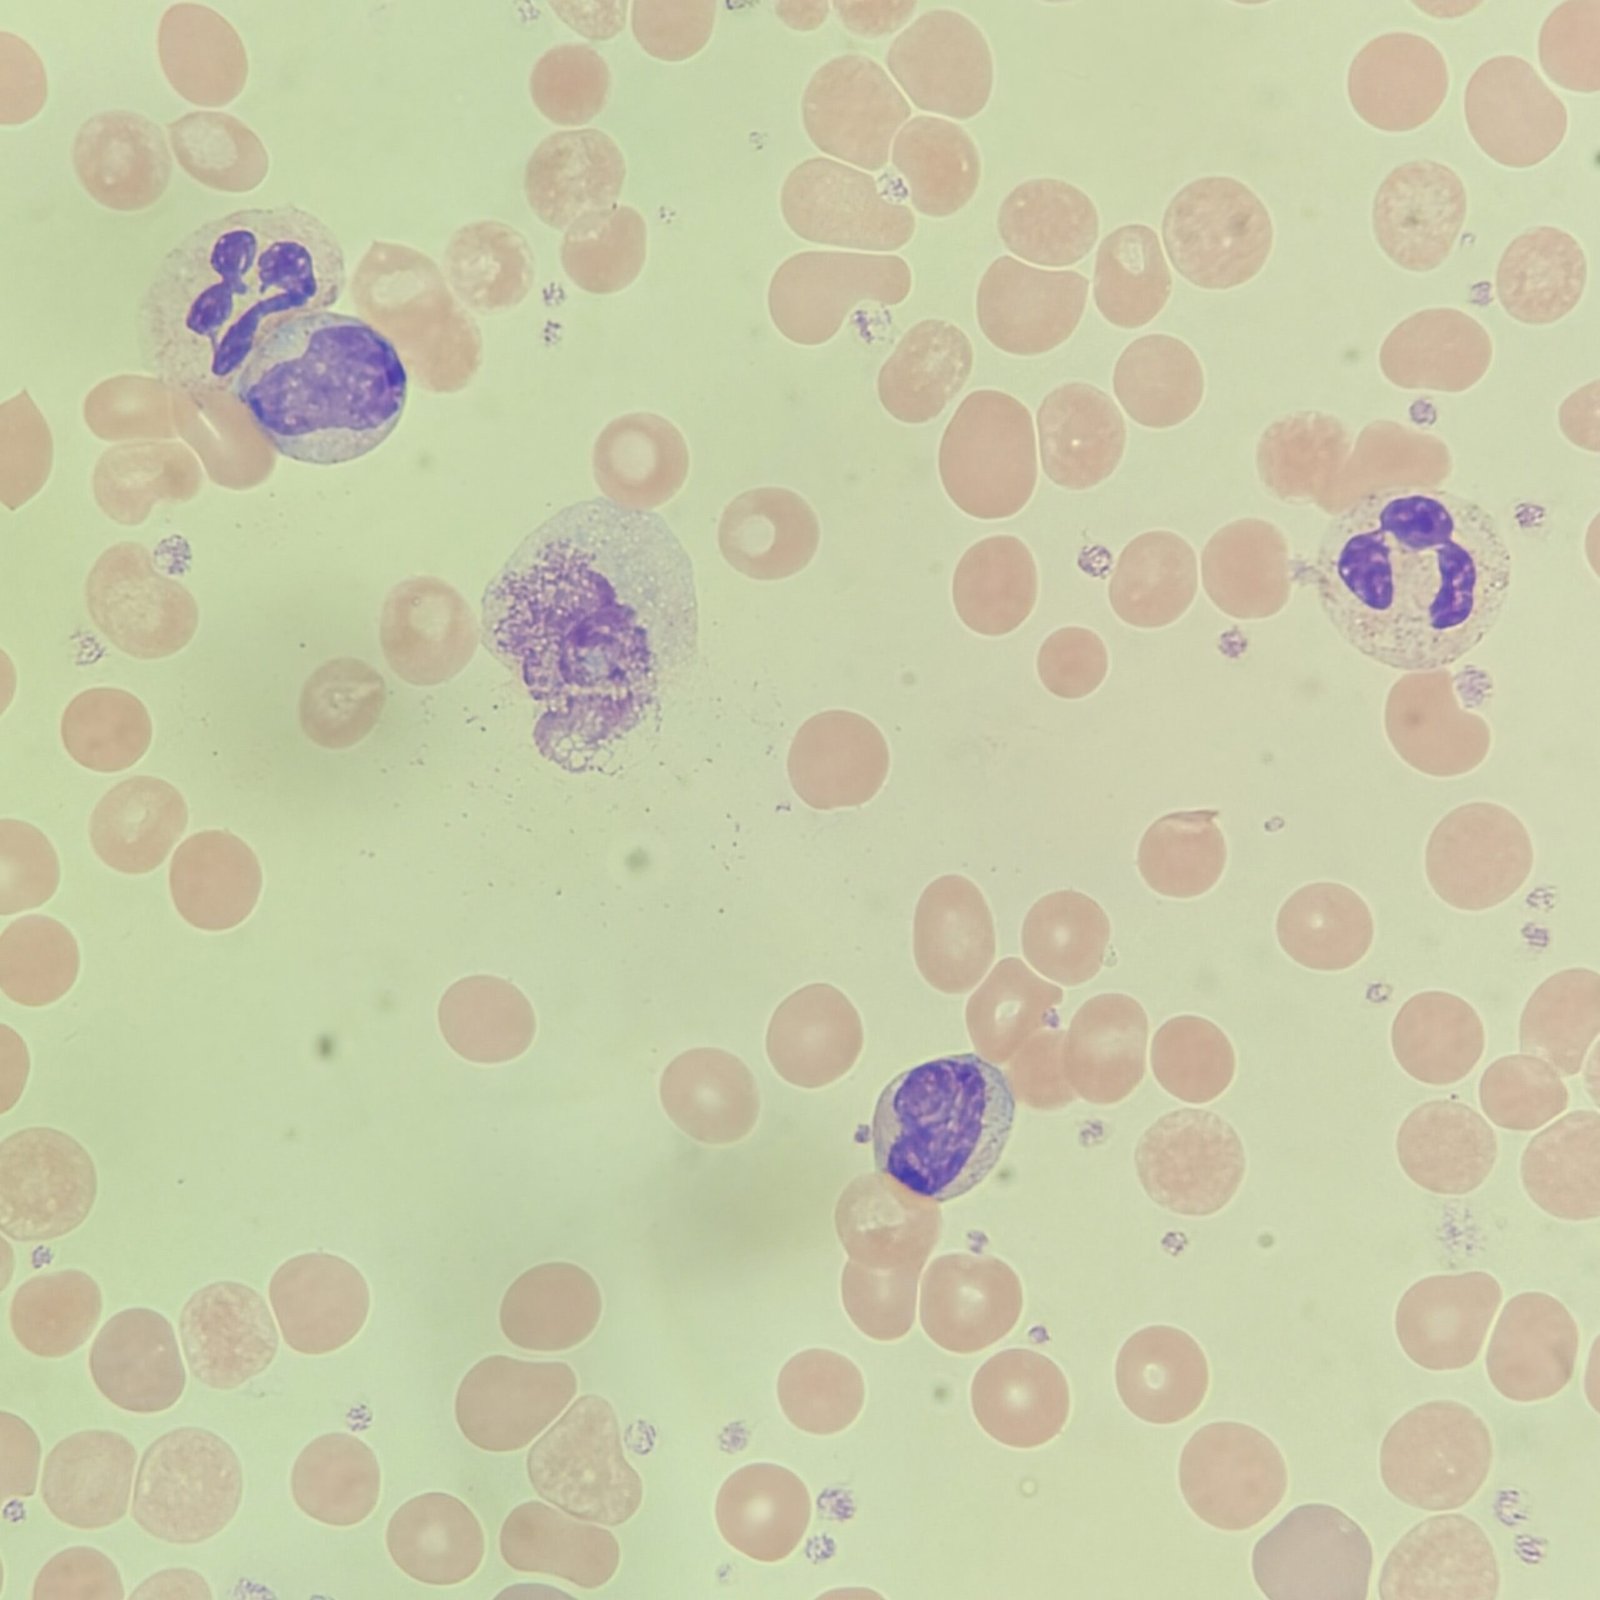
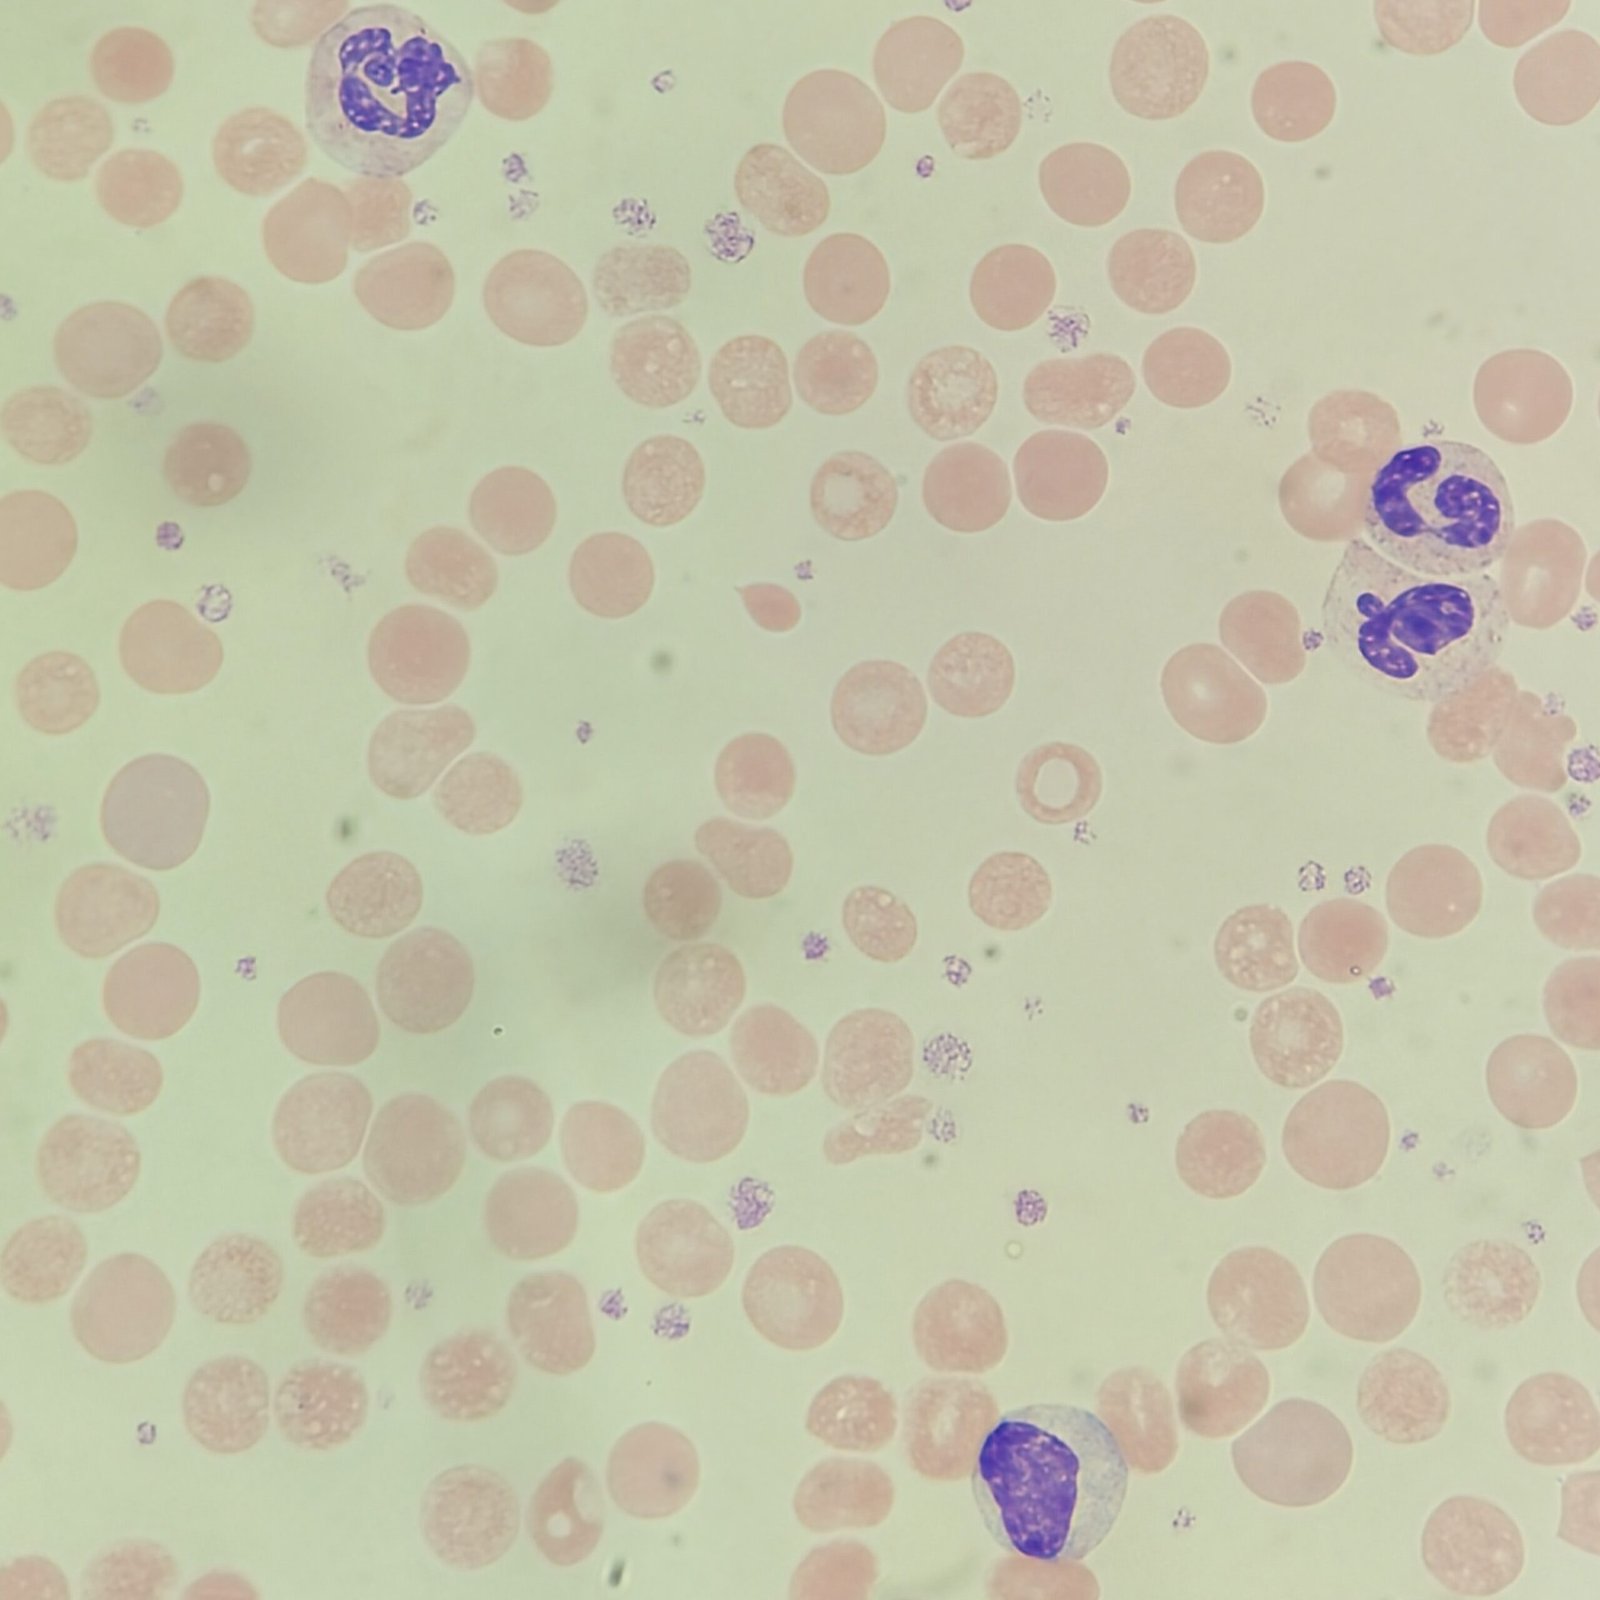
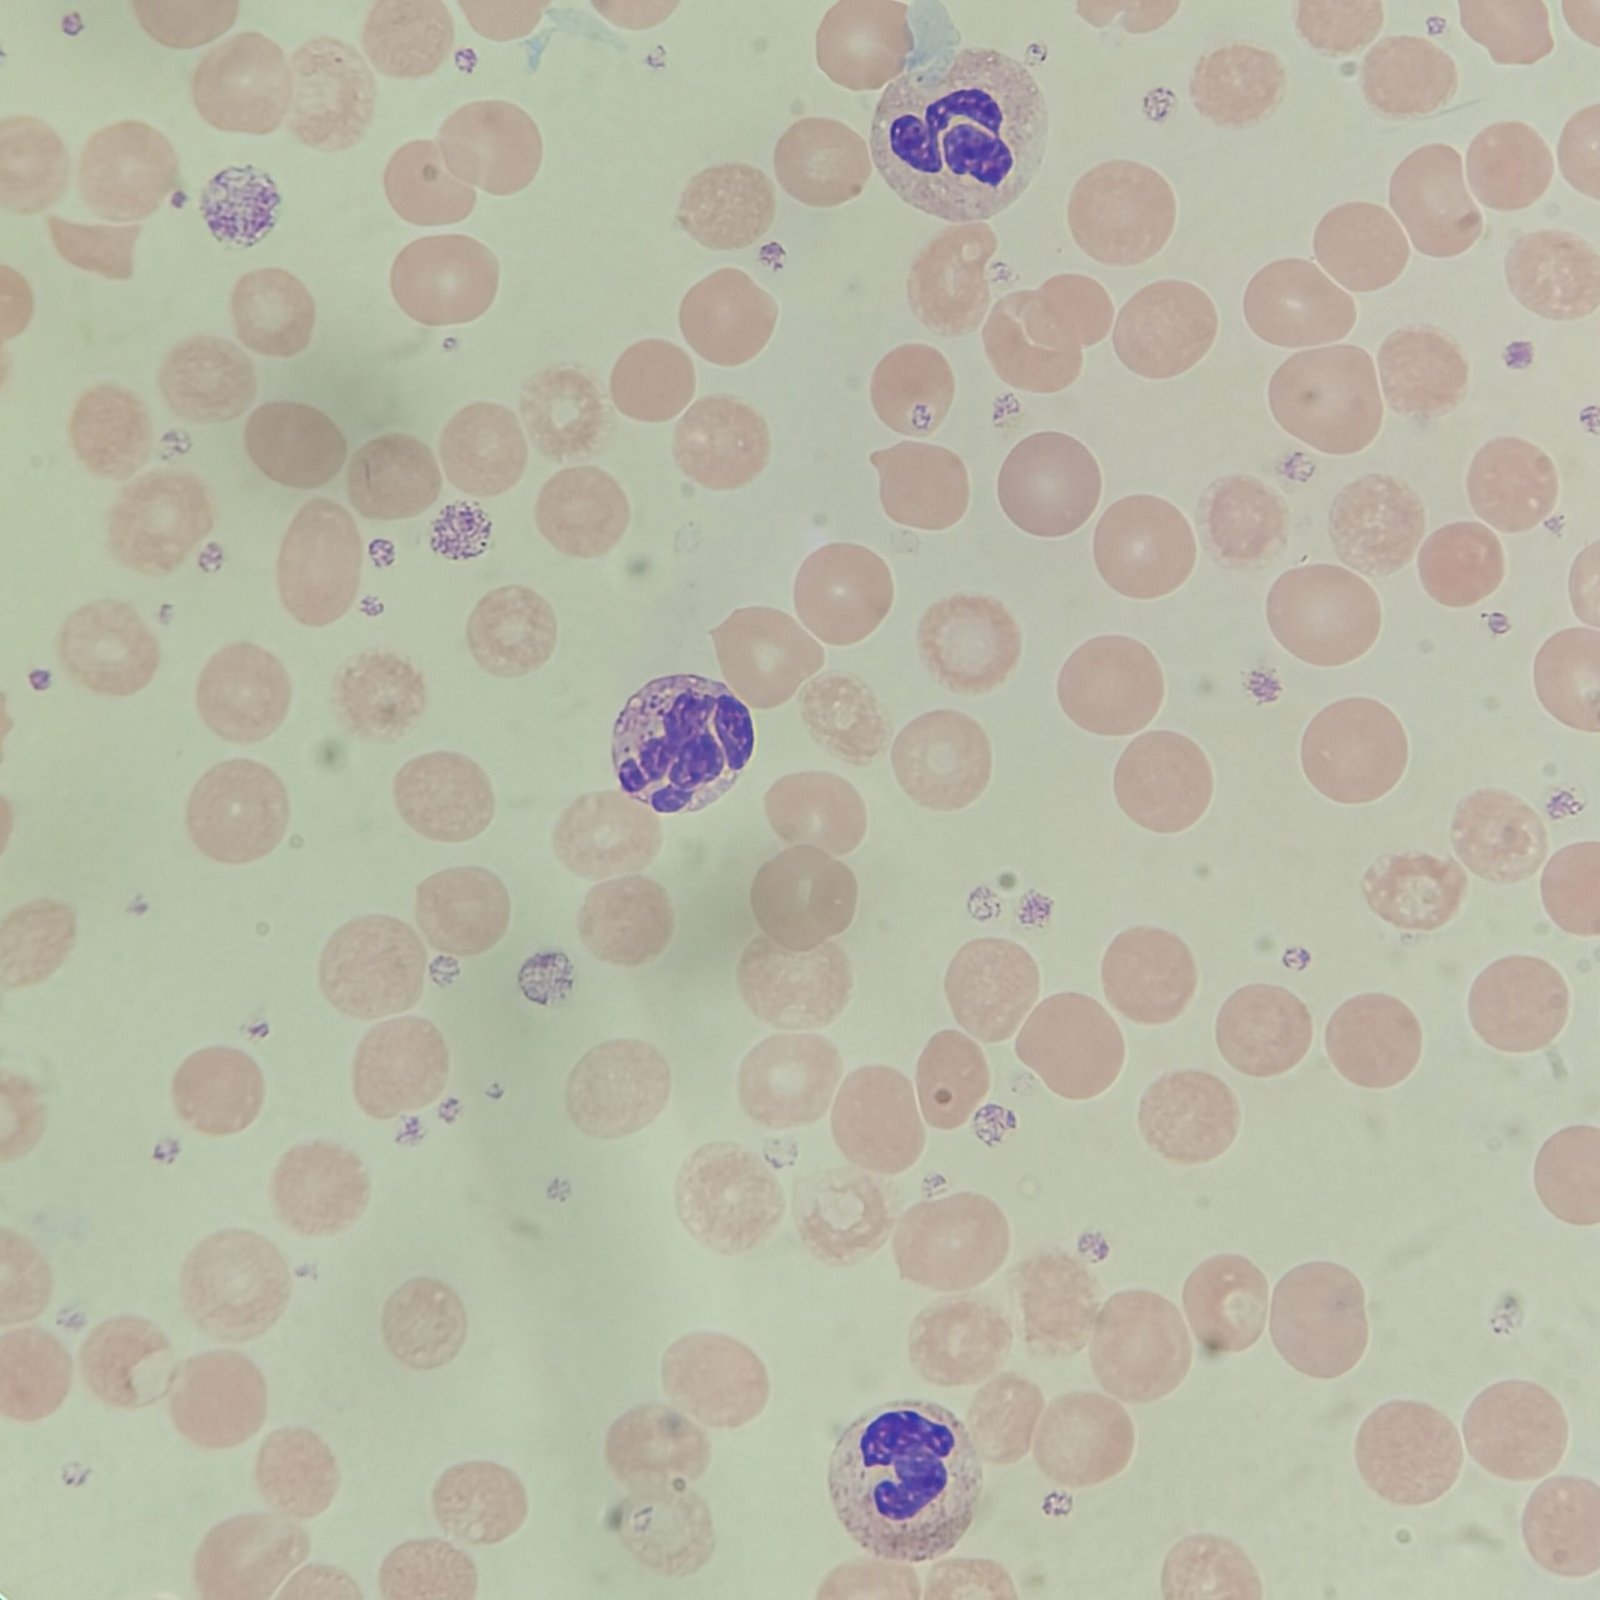

Analyzer Printout
If you would like to go in blind, skip straight to the images below. If you would like to know the analyzer results from the DXH 900, click to reveal.
Analyzer Complete Blood Count
| WBC | 75.5 ↑↑↑ |
| RBC | 3.15 ↓ |
| HGB | 8.6 ↓ |
| HCT | 29.2 ↓ |
| MCV | 92.5 |
| MCH | 27.3 |
| MCHC | 29.5 |
| RDW | 17.8 ↑ |
| PLT | 1006 ↑↑↑ |
| MPV | 10.6 |
Notable Leukocytosis & Thrombocytosis. Anisocytosis also present. Hemoglobin is decreased as well, indicating anemia.
Analyzer Differential
| Neutrophils | 81.9% |
| Lymphocytes | 5.4% |
| Monocytes | 4.4% |
| Eosinophils | 1.6% |
| Basophils | 6.7% |

The neutrophil section of the scatterplot extends upwards, showing larger volumes which is usually indicative of more immature cells. The analyzer flagged for: Left Shift, Immature Grans, & Neutrophilic Blasts.
Blood Smear

Answers
Click to Reveal

Did you get something similar?
Neutrophilic lineage is a continual maturation process instead of distinct stages, so there is some wiggle room in the immature neutrophils. For example, you may have called the same cell a band where I called it a meta or vice-versa.
The big picture is: noticeable left shift in the neutrophils with no blasts & increased basophils.
If you would like an explanation on any of them, please comment! Like I said, there is a certain degree of subjectivity with these (especially with only looking at a picture.) Feel free to also post your differential below for comparison.
